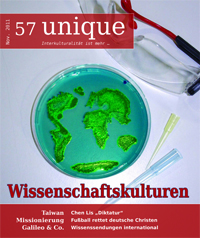

Ausgabe 102:
Liebe Leserinnen und Leser,
in dieser Ausgabe beschäftigt uns das Thema der Anpassung. Anpassung beschreibt einen Prozess, Angepasstheit sein Resultat. Das tückische an der Angepasstheit: Sie erfordert stetige Abweichungen von der Norm, um immer wieder bestätigen zu können, welche Normalität aufrechterhalten werden soll. Das heißt wiederum, dass Diversität per se nichts mit Subversion zu tun hat, sondern integraler Bestandteil einer jeden Normalität ist.
Der Begründer der Psychoanalyse Sigmund Freud prägte den Begriff des Narzissmus der kleinen Differenz. Kurz erklärt: Dem einen 80-Seelen-Dorf ist es sehr wichtig, was sein Nachbardorf tut, aber nicht, was ein hundert Kilometer entferntes Örtchen macht. Je näher, je ähnlicher sich zwei Menschen sind, desto wahrscheinlicher und stärker werden die Aggressionen zwischen ihnen. Müsste man vor dem Hintergrund der Anpassung nicht schlussfolgern, dass dieselbe eigentlich ein Aggressionsverstärker ist? Und da Aggression auch etwas mit der Abwehr von Angst zu tun hat, muss man sagen: Je homogener eine Gesellschaft, desto mehr Ängste muss man unter der so schon brodelnden Oberfläche vermuten.
Wir möchten Euch mit einer Frage zum Lesen dieser Ausgabe teasern: Denkt ihr, ChatGPT hätte Bürgerrechtler wie Lutz Rathenow dazu geraten, ihren Lebenslauf zu riskieren?
Viel Spaß beim Lesen!
Eure Redaktion
Ausgabe 101:
Liebe Leserinnen und Leser,
seit einiger Zeit geistert ein neuer Begriff durch die Medienlandschaft: Polykrise. Im Zeitalter der Globalisierung sind Krisen miteinander vernetzt und verstärken sich oft gegenseitig. Lokale Krisen, wie eine Seewegblockade im Roten Meer oder politische Spannungen um Bergkarabach, können sichschnell zu globalen Krisen entwickeln. Das macht es nicht leicht, die Folgen von politischem, wirtschaftlichem und – so wird es uns zumindest gerne suggeriert – privatem Handeln einzuschätzen. Die Fragen „Was soll ich tun?“, „Wie sollen wir leben?“, „Wohin steuern wir?“ machten uns schon immer zu schaffen. Gegenwärtig scheint dagegegen die Tendenz zu sein, dass globale Konflikte, wie sie uns aus den Medien tagtäglich entgegenschallen – sei es der Krieg Russlands gegen die Ukranie oder die israelische Besatzung palästinensischer Gebiete –, vor allem zu unserer ganz persönlichen Krise werden. Geht es mittlerweile nur noch darum, irgendwie mit den Krisenerscheinungen fertig zu werden, damit wir im Alltag funktionieren? Oder wollen wir Krisen rational verstehen und kommen dabei an unsere Grenzen?
Diese Überforderung erklärt vielleicht auch eine vermehrte Hingabe an nostalgische Gefühle: Erinnerungen an die guten alten Zeiten, in denen die Welt noch in Ordnung war – oder man kramt mal wieder die herzerwärmenden Fotoalben von den Italienurlauben der Kindheit heraus. Birgt das Schwelgen in der Vergangenheit aber auch die Gefahr, den Kontakt zur Wirklichkeit gänzlich zu verlieren? Wie schaffen wir es, den Abstand zur harten
Realität gut auszuloten?
Um diese und weitere Fragen kreist die Ausgabe 101 der unique, die ihr gerade in den Händen haltet. Wir wünschen viel Freude und Inspiration bei der Lektüre!
Eure Redaktion
Ausgabe 100:
Liebe Leserinnen und Leser,
die unique wird dreistellig! Gedauert hat das nicht weniger als 23 Jahre, was fast dem Durchschnittsalter unserer Redaktion entspricht. Der Weg zur aktuellen 100. Ausgabe war gesäumt von Höhen und Tiefen. Ganze 13 Personen wurden im Amt der Chefredaktion verbraucht. Rund 300.000 Exemplare wurden gedruckt. Unzählbar viele Redakteurinnen und Redakteure gaben sich in unseren Räumlichkeiten im Haus auf der Mauer die Klinke in die Hand. Voller Demut blicken wir zurück auf ein Medium, das vor uns begann und auch nach uns existieren wird. Zur Feier dieser besonderen Ausgabe widmeten wir uns einem Thema, das uns schon eine ganze Weile auf dem Herzen liegt, denn der Blick zurück in die eigene Geschichte entdeckt auch unschöne Momente, denen wir uns stellen müssen. Kommt mit ins Jahr 2009, in dem ein Skandal ungekannten Ausmaßes unsere kleine Zeitschrift erschütterte und sie an den Rand ihrer Existenz führte. Vieles würden wir heute anders machen, aber ist es nicht zu einfach, aus heutiger Perspektive die Vergangenheit zu verurteilen? Des Weiteren bietet euch diese Ausgabe Artikel zur Sprache der Psychologie, Taylor Swift, Jenaer Bettelmönche, Diamantenesel, rechte Jugend, Bulgakow und die vom Aussterben bedrohte, letzte Bastion männlichen Lebens: die Garage.
Wir wünschen viel Vergnügen bei der Lektüre!
Eure Redaktion
Ausgabe 99:
Liebe Leserinnen und Leser,
es ist fast Tradition in der unique, immer dann, wenn Israel verstärkt in den Fokus gesellschaftlicher Diskurse gerät, eine eigene Ausgabe dazu zu publizieren. Der brutale Angriff der Hamas auf israelische Kommunen – und gerade auf jene Kibbuzim, die für ihre propalästinensische Haltung bekannt sind – ist so ein Anlass. Seit dem 7. Oktober 2023 ist für Millionen von Menschen nichts mehr wie zuvor. Die Ausgabe 99, die ihr in euren Händen haltet, bildet unsere zeitversetzte Beschäftigung mit dem Thema ab. Und es hat uns auch nicht überrascht, dass wir ausgerechnet bei diesem Thema innerhalb der Redaktion selten einer Meinung waren. Wir hoffen also, einige Perspektiven auf den über ein Jahrhundert langen zionistischen Kampf – der mit Theodor Herzl noch eine klar sozialistische Form
hatte, wovon heute nur noch wenig übriggeblieben ist – zu geben. Gleichzeitig soll diese Ausgabe auch ein Abbild einiger Debatten darstellen, die in der deutschen Gesellschaft umhergeistern. So unterschiedlich die Haltungen innerhalb der Redaktion auch sind – wir alle vertreten die These, dass Kontextualisierung nicht gleich Relativierung bedeutet. Es ist eben bei jedem Krieg etwas von einer Ambivalenz spürbar zwischen dem Versuch, aktuelle Feindschaften zu historisieren, zu rationalisieren – was schnell in ein Mythologisieren abrutschen kann –, und dem Versuch, gegenwärtig sich aufdrängende Ereignisse als singulär und ahistorisch zu (v)erklären. Dass die israelische Besatzung der palästinensischen Gebiete ein wesentlicher Faktor für die Entstehung terroristischer „Energien“ ist, ist unbestreitbar. Jedoch lassen sich Terrorakte nicht allein darauf reduzieren.
In solch aufrührenden Zeiten sollte man nicht vergessen, seinen Blick immer wieder zu weiten und bei anderen Themen verweilen zu lassen. Auch dazu laden wir in dieser Ausgabe ein.
Ausgabe 98:
Liebe Leserinnen und Leser,
es ist schon bemerkenswert, wie aus dem 20. Jahrhundert das 21. werden konnte. Das Jahrhundert der „alternativen Modernen“ und des grenzenlosen und entgrenzten Optimismus gebar das, was der Politikwissenschaftler Francis Fukuyama bereits 1989 als „das Ende der Geschichte“ bezeichnete. Seine These heißt nicht, wie ihm oft unterstellt wird, dass der liberal-demokratische Kapitalismus als Sieger und somit als Träger zeitloser Wahrheiten aus dem Kalten Krieg hervorgegangen sei. Nein, Fukuyama behauptet, dass es gerade der Systemkampf war, der eine lebendige Politik triggerte – im Sinne einer Suche nach der besseren Gestaltungsweise, Gesellschaft zu organisieren. Das Ende dieses Systemkampfes bedeutet für Fukuyama also das Ende von Politik überhaupt. Die 1990er, sagt er, erlebten den Aufschwung der Technokratie: Globalisierung, Marktliberalisierung und Individualisierung wurden als objektiv notwendige Tatsachen gesetzt, in deren Richtung der Berufspolitiker nur die richtigen Stellschrauben zu drehen hätte. „Politik“ nach Handbuch. Politische Argumente wurden in „vernünftig“ und „unvernünftig“ eingeteilt. Umso interessanter, dass seit 2016, dem Jahr der Trump-Wahl und des Brexits, die „Unvernunft“ global immer mehr an Beliebtheit zu gewinnen scheint. Anlässlich solcher Überlegungen präsentieren wir euch einige Texte, die sich mit dem Komplex „Utopie“ auseinandersetzen. Dabei haben wir bewusst versucht, eben nicht auf Dystopien zu sprechen zu kommen. Denn: Fällt es nicht auf, dass die letzten Jahre eine Retromanie an Fahrt aufgenommen hat, die ihren Kontrast darin erfährt, dass jede von der Zukunft handelnde Netflix-Serie dystopisch ausfällt? Warum scheint es immer schwieriger zu werden, positive Utopien zu entwickeln? Und welche kulturhistorischen Vorlagen gibt es, um solche Utopien wieder zu ermöglichen?
Ausgabe 97:
Liebe Leser:innenschaft,
die Ausgabe 97 hat ganz schön auf sich warten lassen. Wir bitten dafür um Verzeihung und hoffen, dass das nicht wieder passiert. Die Ausgabe 96 erschien im November letzten Jahres – in der Zwischenzeit hatten wir Großes vor und wir waren mit diesem Heft eigentlich bereits im Februar fertig, doch es ließ sich leider doch nicht erfüllen. Das hat uns ziemlich enttäuscht und motivationslos werden lassen. Mittlerweile haben wir neuen Mut gefasst und freuen uns bereits auf die nächste Ausgabe! Für die Ausgabe 97 haben wir uns jedenfalls ein Thema ausgesucht, das während der Corona-Zeit ebenso virulent wurde wie das Virus selbst, nämlich Einsamkeit, psychische Gewalterfahrungen und
Prokrastination. Von da aus haben wir uns inspirieren lassen und laden zu unseren Sprechstunden ein.
Ausgabe 96:
Liebe Leser:innen,
in diesem Heft wollen wir uns mit Krieg und Frieden beschäftigen, motiviert durch den Angriffskrieg Russlands gegen die Ukraine. Gastautor:innen und Interviewpartner: innen unterstützen uns dabei, diese Themen auf angemessenere Weise anzugehen, als wir es allein hätten tun können. Warum aber jetzt eine Ausgabe über Krieg? Nur weil Europa nun näher betroffen ist? Wir sollten akzeptieren, dass das ein Hauptgrund ist, was nicht schlecht sein muss. Denn so gerät auch der Wunsch nach Frieden immer mehr in den Fokus, worum wir uns auch in dieser Ausgabe bemühen. Wie ihr sehen könnt, haben wir außerdem mit einigen Veränderungen bezüglich unseres Erscheinungsbildes begonnen – bleibt gespannt auf die Weiterführung dieses Projekts!
Ausgabe 95:
Liebe Leser:innenschaft,
wir wissen nicht, ob ihr’s wusstet, aber wir befinden uns mitten in den Hundstagen. Das Wort bezeichnet den heißesten Abschnitt des Jahres in Europa. Als dieses Wort Anfang der römischen Königszeit im 8. Jahrhundert v. Chr. erfunden wurde, hatte es aber noch die Bedeutung des Aufgangs des Sternbilds Canis Major (Großer Hund). Die Periode der heißesten Tage spannt sich heute zwischen dem 23. Juli und 23. August auf. Und ja, es gibt da die Sommermenschen, die sich mehr von diesen Hitzetagen wünschen, die vielleicht sogar froh darüber sind, dass durch die globale Klimaerwärmung Deutschland bereits im Jahre 2050 das Klima Italiens haben könnte. Aber es gibt auch noch diejenigen, die versuchen, diesen Teufelskreis zwischen steigenden Durchschnittstemperaturen und dringender werdenden Veränderungen zu durchbrechen. Einen frühen Schritt ging bereits der Club of Rome, als er vor 50 Jahren den Bericht Die Grenzen des Wachstums. Bericht des Club of Rome zur Lage der Menschheit veröffentlichte. Es sollte eigentlich um die Zukunft der Weltwirtschaft gehen, doch vielmehr wurde gezeigt, dass die Weltwirtschaft gar keine Zukunft hat, sofern nicht auf übermäßige Ausbeutung der Ressourcen verzichtet wird. Um dieses Problem zu lösen, können wir unsere Hoffnungen nicht auf innovative Technologien stützen, so einer der Schlüsse des Club of Rome, sondern müssten ernsthaft über einen radikalen politischen und wirtschaftlichen Wandel nachdenken. Dieser Wandel wird, wie einer unserer Autor:innen aufzeigt, auch einen Perspektivwechsel bezüglich der Endlichkeit unseres Lebens bedeuten. In diesem Heft wollen wir aber auch zeigen, dass diese heiße Jahreszeit nicht nur die Sommerpause kennt, in der Kunst und Kultur stillstehen – ganz im Gegenteil, erst im Sommer eröffnen sich für viele Kulturstätten neue Möglichkeiten, wie die Kasseler documenta fifteen und die hitzigen Diskussionen um sie herum zeigen. Auch beschäftigt sich ein ganzes literarisches Genre mit dem Sommer, wo allzu oft von dem „Sommer unseres Lebens“ oder dem „Sommer, der alles verändert“ gesprochen wird – welche Ideologie damit verbunden ist, könnt ihr im Ressort WortArt lesen.
Ausgabe 94:
„Wie geht’s dir?“ – „Ach, ganz gut“ antwortet man beflissen, dabei fühlt man sich eigentlich beschissen. Die Situation kennt wohl jede*r gut. Ein typisches Beispiel für eine scheinbar harmlose Alltagslüge. Man sagt, eine Person flunkere zwischen zwei bis zweihundert Mal am Tag. In jeder*jedem von uns stecken kleine Schandmäuler, Wortklauber*innen, Schaumschläger*innen und Lügenpeter. Dass die Lüge oft spannender als die Wahrheit ist, weiß schon Käpt’n Blaubär, einer der dreistesten Lügner der deutschsprachigen Literaturgeschichte: „Es ist so, als würde man der Wirklichkeit ein schöneres Kleid geben“. Aber was ist eigentlich eine Lüge und wann wird aus dem schönen Kleid eher ein hässlicher Lumpen? Ist etwas verschweigen auch schon eine Lüge? Ist das Nicht-Abbilden von einer Wahrheit auch schon eine Schwindelei? Gibt es eine*n Ur-Lügner*in oder hat sich die Lüge einfach durch die Jahrhunderte weitergetragen, bis sie selbst als Wahrheit akzeptiert wurde. Sind universitäre Kanones Lügen? Verschweigen und Umdeuten waren schon immer politische Mittel: Das Einstreuen von Euphemismen wie ‚Kollateralschaden‘ oder ‚special military operation‘ benennen im Sinne des Orwellschen ‚Neusprechs‘ nicht, was ‚wahr‘ ist, sondern verschleiern und verzerren die Realität. Im Falle der Colonia Dignidad führte das Schweigen der Deutschen Botschaft und des Auswärtigen Amtes zu 40 Jahren Folter, Mord und sexualisierter Gewalt. Schweigen ist auch Gewalt und Verdrängen. Und wann schlägt es in die Lüge um? Erfindet man ein eigenes Land namens Poyais wie General Sir Gregor MacGregor im Jahre 1823 oder wiederholt man die Halbwahrheiten, gefunden in den Untiefen des Telegram-Chats. Fake News verbreiten sich laut dem Massachusetts Institute of Technology (MIT) sechsmal schneller als ‚wahre‘ Nachrichten. Was verführt uns an der Lüge? Bietet sie ein Entflechten der komplizierten Wahrheit, eine Flucht vor dem Eingeständnis, dass die Wahrheit oft vielschichtig ist? In der 94. Ausgabe der unique haben wir uns mit den verschiedenen Erscheinungsformen von Lüge und Wahrheit beschäftigt. Mit der Sprache als Instrument der Wahrheit und der Lüge. Unsere Artikel versuchen auszuloten, wie sich Realitäten verzerren, wenn verdrängt, verschleiert oder mit vollster Absicht gelogen wird. Beim Lesen, Wundern und fröhlichem Weiterflunkern wünschen wir viel Freude
P.S.: Wenn Dir die Ausgabe wegen des Titelbildes aufgefallen ist, dann findest Du den Künstlernamen unter der Rubrik credits to. Du malst, zeichnest oder fotografierst selbst und hast Lust, das Titelbild der unique zu gestalten? Dann melde dich einfach bei uns.
Ausgabe 93:
Sex hat eine Geschichte, eine überwiegend leidvolle Aneinanderreihung von Ungerechtigkeiten. In den letzten 100 Jahren hat sich aber Einiges getan: Bis in die 1960er Jahre hinein wurde die kleinbürgerliche Sexualmoral kaum hinterfragt, oft genug sollte das Thema Sexualität versteckt und schambehaftet behandelt werden. Es war gerade diese Verborgenheit des Sexuellen, die Raum für eine sexuelle Verborgenheit schuf, um zu verschleiern, was oft genug mit Schmerz, Schuld und Gewalt verbunden war und ist. Ist der römische Gott der Liebe, Amor, nicht das Beispiel dafür? Ja, Amor schafft Liebe. Aber um das zu tun, muss er Menschen mit Pfeil und Bogen erschießen, was ihm auch selbst zum Verhängnis wurde (S. 18). Es war unter anderem die 68er-Bewegung, die dem öffentlichen Schweigen über Sexualität ein allmähliches Ende bereitete. Enttabuisierung ist hier das Stichwort für unzählige emanzipatorische Kämpfe, wovon nicht nur Frauen*, sondern auch die Sexualerziehung der Schüler*innen (S. 10) heute profitieren. Es ist einfach zu sehen, dass Sexualität ein an Problemen nicht armes und gerade deshalb politisches Thema ist. Diese Erkenntnis erlaubt es, über Sexualität sowohl privat, wie in der Amateurpornographie (S. 6), als auch öffentlich, wie in der Literatur (S. 24-26), zu verfügen und sich ihrer zu bemächtigen. Noch verzwickter wird die Lage, wenn das Verhältnis von Sexualität und Liebe ins Blickfeld rückt. Gehen Liebe und Sex zwingend miteinander einher? Dass es das Phänomen der Asexualität und Aromantik gibt, spricht deutlich dagegen (S. 9). Und selbst wenn Liebe und Sex verbunden sind, machen sich, zum Beispiel mit Blick auf Pädophilie, gesellschaftliche Akzeptanzprobleme breit (S. 14). Die Frage, die bereits die 68er stellten, lautet so: Was ist normal? Was ist unnormal oder gar ‚abnorm‘? Nicht zuletzt hängt die Frage der Normalität davon ab, von welcher Position aus beurteilt wird, wie Dr. Alexander Zinn in seinem Gastbeitrag zur Homosexuellenverfolgung im Dritten Reich und den folgenden Jahren darlegt (S. 17). Schließlich muss gefragt werden, ob Liebe überhaupt ‚normal‘ ist. Beginnt Liebe nicht mit einem Fall, wie man im Englischen und Französischen so schön sagt? Ist der ‚Fall in die Liebe‘ nicht immer auch einer, der Risiko, Mut und Verzweiflung bedeutet? Um ein Hollywood-Klischee zu bemühen: An einem Tag, der alltäglicher nicht sein könnte, gehst Du einkaufen, Dein Bio-Apfel-Plastikbeutel zerreißt, und ein hilfsbereiter junger Mann hilft beim Aufsammeln – doch plötzlich fällt Dir, obwohl scheinbar nichts Besonderes an ihm ist, auf, dass er der symbolische Retter der Stunde ist, der Dir ein ‚Jenseits des Alltags‘ eröffnet. Plötzlich wird Dir klar, dass Dich die Liebe wie ein Schicksalsschlag getroffen hat. Wie Dir, liebe*r Leser*in, vielleicht aufgefallen ist, geht es in dieser Ausgabe vor allem um die ernsten Seiten von Liebe und Sexuailität. Wir hoffen, dass Du trotzdem, oder gerade deswegen, wichtige Gedanken und neue Perspektiven aus diesem Heft gewinnen kannst – ob angenehme oder unangenehme, uns begleitet hier dieselbe Ambivalenz, die Liebe und Sex eben innewohnt. Wir wünschen Euch viel Lust und Freude beim Lesen!
P.S.: Wenn Dir die Ausgabe wegen des Titelbildes aufgefallen ist, dann findest Du den Künstler*innennamen künftig unter der Rubrik credits to. Erstmalig begleiten Dich auch unter Vol. unique Empfehlungen der Redaktion – in dieser Ausgabe musikalischer Natur.
Ausgabe 92:
Wir schrieben das Jahr 2001. In Deutschland wurde noch mit D-Mark bezahlt, das Lied „What if“ von Kate Winslet stürmte Platz 3 der Charts und eine kleine Gruppe Studierender und interkulturell Interessierter fand sich zusammen, um gemeinsam eine Zeitschrift zu gründen – in dieser bewegten Zeit wurde die unique geboren. Layouttechnisch noch in den Babyschuhen, etablierte sie sich bald als das interkulturelle Studierendenmagazin für Jena, Weimar und Erfurt. Heute, 20 Jahre später, können die Redaktionsmitglieder auf zwei turbulente Jahrzehnte zurückbli-cken – und unsere Leser*innen in dieser Sonderausgabe auch: beginnend in unserem exklusiven Jubiläumsteil ab Seite 26. Ein wenig nostalgisch schaut unser dienstältester Redakteur auf längst vergangene unique-Tage (ab Seite 28) zurück, während auf Seite 27 die aktuelle Chefredakteurin aus dem Nähkästchen plaudert und berichtet, was bei den online abgehaltenen Redaktionssitzun-gen zu Coronazeiten vonstatten geht. Besonders dankbar sind wir einigen ehemaligen unique-Re-dakteur*innen für die Grußworte und Anekdoten, welche ihr ab Seite 30 entdecken könnt. Wer sich schon immer gefragt hat, was eigentlich EinBlick, WeitBlick, LebensArt und WortArt bedeuten, kann das in unserem dictionarique ab Seite 24 nachschlagen und sich auch einige schöne Wörter mit -ique-Suff ix erklären lassen. Nur das Wort „unique“ werdet ihr dort nicht finden, denn diesen Begriff und seine sprachgeschichtlichen Hintergründe beleuchtet Prof. Dr. Thomas Honegger in seiner Kolumne auf Seite 33. Was die unique in ihren 20 Jahren mit sechs ausgewachsenen Elefan-ten, dem Shanghai Tower und einer Reise von Jena nach Ilmenau zu tun hat, erfahrt ihr in unserer statistique ab Seite 36.Doch nicht nur die unique feiert ihr Jubiläum. Vor 20 Jahren kam zum Beispiel auch Steven Spiel-bergs A.I. – Artifi cial Intelligence in die Kinos – Zeit, diesen damals missverstandenen, außer-gewöhnlichen und ambivalenten Science-Fiction-Film über einen ebenso süßen, wie abgründigen Roboter neu zu betrachten (Seite 19). Auf das Leben und Schaff en des einfl ussreichen, aber auch kontroversen Künstlers Joseph Beuys blicken wir anlässlich seines 100. Geburtstags auf Seite 16 zurück. 2021 ist das Jahr des 200. Todestags Napoleons. Mit dem nach dem französischen Kaiser benannten Zeitalter der Revolutionen beschäftigt sich ein Bildband der Historikerin Ute Planert, der auf Seite 13 besprochen wird.Diese besondere Ausgabe steht nicht nur im Zeichen unseres Jubiläums, sondern auch „zwischen gestern und morgen“: In diesem Zustand befanden sich zahlreiche Studierende, die im Winterse-mester 2020/2021 ihr Studium begannen und sich statt mitten im aufregenden Studierendenleben in einer Murmeltiertag-Schleife aus Zoom-Meetings und Vorlesungsstreams wiederfanden: Über ihre Erlebnisse als Studienanfängerin in Pandemiezeiten berichtet eine unserer unique-Redakteu-rinnen ab Seite 6. In unserem memorique(Seite 11) befassen wir uns diesmal mit den Kontroversen um die Büste des antisemitischen Philosophen Jakob Friedrich Fries am Philosophischen Istitut der FSU Jena – und berichten von einem Seminar, bei dem Studierende neue Denkmalkonzepte für eine Geschichts- und Erinnerungskultur von morgen entwickelt haben.
Zu unserem Geburtstag schenken wir euch, liebe Leser*innen, heute nun diese Ausgabe und wünschen viel Spaß beim Lesen!
Ausgabe 91:
Ahoi, ihr Matrosinnen, Matrosen und Landratten! Wir aus der unique-Redaktion haben uns diesmal was Besonderes für euch überlegt. Nachdem wir Schneestürme, ein zugeschneites Jena und eisige Tage überstanden haben, leiden wir nun schwer an Fernweh, Vitamin-D-Mangel und bald noch an Skorbut. Deshalb haben wir uns gedacht, dass eine Ausgabe, die allein der Seefahrerei gewidmet ist, genau das Richtige wäre.
Folgende Artikel haben wir für euch im Schlepptau (inklusive mal mehr und mal weniger lustige nautische Wortwitze): Es erwartet euch ein Interview mit der Erfurter Lokalgruppe der Seebrücke (Seite 8), sowie ein Beitrag zur Seenotrettung an Europas Küsten und den Gesetzen des Meeres, die sich nicht an die Flüchtlingspolitik binden lassen (Seite 11). Von echten Piraten – keine romantisierten Freiheitskämpfer aus Erzählungen und Filmen – könnt ihr ab Seite 16 in unserem Gastbeitrag lesen. Nun sagt doch einmal: Wie habt ihr‘s mit der Religion? Welche außergewöhnlichen Religionen ihren Ursprung und ihre Geschichte eng mit dem Meer vertaut haben, erfahrt ihr ab Seite 19 – und was zum Klabautermann sind Pastafari?
Falls ihr auf der nächsten Party (wann auch immer diese sein wird) mit eurem Wissen brillieren wollt, solltet ihr unbedingt in unserem Seemanns-ABC (Seite 23) schmöckern. Hier erfahrt ihr nicht nur, wer der eigentliche Entdecker Amerikas (Spoiler: es war nicht Kolumbus) ist, sondern auch, woher das Wort „Quarantäne“ ursprünglich stammt. Und weil wir alle in dem selben Boot mit klimabedingtem starken Seegang sitzen, lohnt es sich, darauf zu achten, wie viel Energie wir in welche Energie stecken. Also trotz Wind und Wetter: Macht euch auf zu neuen Ufern – eine Aktivistin bei Fossil Free Münster erklärt, wie Divestment funktioniert und warum es so wichtig ist (Seite 13).
Gegen den Wind ihres Stammes segelt Vaiana über das Riff hinaus und trifft auf den Halbgott Maui. Dass Disney aus ethnischen und sozial-historischen Begebenheiten nicht nur Seemannsgarn spinnen kann, beweist dieser Film rund um die polynesische Kultur – von einer Auseinandersetzung mit Disney und dem Film Vaiana – Das Paradies hat einen Haken schreibt unsere Autorin ab Seite 26.
Wenn in der Liebe ein stürmischer Wind weht, können die Wogen mit einer geknoteten Halskette einfach wieder geglättet werden und die begehrte Piratenbraut verzeiht noch jedes Holzbein – eine Anleitung zum Selbstknoten findet ihr auf Seite 34. Wenn ihr dennoch in die stürmische See stürzt und über Bord geht, nehmt euch ein Beispiel an unserem klassiquer (Seite 32): Robinson Crusoe musste ungefähr lange 28 Jahre auf einer einsamen Insel zubringen, nachdem sein Schiff kenterte.
Das Leben ist wie das Segeln – man kann weder das Wetter noch das Wasser ändern, aber immerhin das Beste aus der Situation machen. Diese Weisheit und wie die Seemannssprache ins Deutsche Einzug gehalten hat, erklärt Thomas Honegger in seiner Kolumne auf Seite 33. Und das ist kein Seemannsgarn – versprochen!
Wir wünschen euch viel Freude am Lesen!
Ausgabe 90:
Verpuppt. Sei es die Metamorphose von einer kleinen Raupe zu einem wunderschönen Schmetterling, das Zusammensetzen mehrerer Matroschka-Puppen oder die Entwicklung von der ersten Idee bis hin zum fertigen Heft – all das bedeutet Veränderung. Die Bedeutung dessen war Heraklit bereits um 500 v. Chr. klar, als er postulierte: „Die einzige Konstante im Universum ist die Veränderung“. Stillstand liegt weder in der Natur der Dinge, noch in der der Menschen oder gar der gesamten Welt. So ist das unerbittliche und unaufhörliche Wesen des Wandels unser stetiger Begleiter und der Umgang mit ihm sicherlich eine der schwierigsten Herausforderungen des Lebens. Doch könnte man die Erkenntnis der Weiterentwicklung nicht als ebenso spannend und faszinierend betrachten? Die Entwicklung von unseren frühen Vorfahren, die auf Bäumen hausten und Feuer und die damit einhergehenden Möglichkeiten noch nicht zu nutzen wussten, zum modernen Homo sapiens sehen wir schließlich auch nicht als etwas Erschreckendes, sondern als etwas Gewinnbringendes an. Entwicklung brachte Fortschritt.
Eine Entwicklung in der Evolutionsgeschichte vollzog sich mit den Anfängen Darwins Evolutionstheorie und -forschung. Die französischen Zeichner Fabien Grolleau und Jérémie Royer bringen seine ersten Entdeckungen auf eine ganz besondere Art und Weise zu Papier: In einer Graphic Novel legen sie Darwins Forschungsreise neu auf. Unsere Rezension und ein paar Eindrücke aus dem Comic könnt ihr euch auf den Seiten 15-17 ansehen.
Nicht nur Veränderungen innerhalb der Vergangenheit sind interessant – es lohnt sich auch einen Blick in die Zukunft zu werfen. Wenn es nun um die Frage nach der Zukunft unserer Erde geht und die Tage der Menschheit als gezählt gelten, erfüllt uns das mit Angst. Doch was ist dran an den düsteren Prognosen? Schließlich sollte die Erde ja auch schon im Jahre 2012 untergehen. Der Archäologe Robert L. Kelly räumt in seinem Sachbuch mit den Mythen über Mayas, Neandertaler und Zukunftsszenarien auf. Die Rezension von Warum es normal ist, dass die Welt untergeht findet ihr auf Seite 12.
Die Verbindung von Vergangenheit und Gegenwart zieht Thomas Honegger in seiner aktuellen Kolumne auf Seite 24. Er beschreibt die Geschichte des Buches – von seinen Anfängen in Wäldern bis hin zu heutigen modernen Laptops und E-Readern. Dabei betrachtet er besonders die Ethymologie der Bezeichnungen für Schriftstücke.
Wie man sich mit der Historie auseinandersetzen und aus ihr lernen kann, zeigt die neugegründete Initiative Historiker*innen für ein weltoffenes Thüringen (Seite 6). Eine andere Art der geschichtlichen Aufarbeitung findet im Goethe- und Schiller-Archiv in Weimar statt. Ab Seite 8 könnt ihr einen Einblick in die Arbeitsweisen und Aufgabenfelder des Archives gewinnen.
Wie der Umgang mit Schicksalsschlägen einen Menschen gefangen halten kann, wenn er Schmerz und Hass nicht loslassen kann, zeigt Autorin Emily Brontë in ihrem Klassiker Sturmhöhe. Ab Seite 20 erfahrt ihr mehr über das Werk sowie über die Autorin selbst.
Für Ausgabe 90 sind wir nun am Ende angekommen. Veränderungen wird es für sie nicht mehr geben. Für uns aber schon, wenn wir das fertige Exemplar in den Händen halten, heißt es: auswerten, lernen und weitermachen. Somit ist auch diese Ausgabe ein Zeugnis unserer Entwicklung.
Wir wünschen euch viel Freude am Lesen!
Ausgabe 89:
„Life has its beginning and its maturity comes into being when an individual rises above self to something greater. Few individuals learn this, and so they go through life merely existing and never living”, pries Martin Luther King im Jahr 1957 nicht nur den Altruisms an, sondern stellte ihn gleich auf eine Stufe mit dem Leben an sich. Sicher, Selbstlosigkeit ist beeindruckend. Aber ist es überhaupt ein realistisches Szenario, das einer der größten Männer des 20. Jahrhunderts hier entwirft? Kann der Mensch seinen Egoismus überwinden? Handelt es sich bei Selbstlosigkeit nicht eher um eine Idealvorstellung? Solche Fragen beschäftigten die Menschheit schon seit Anbeginn und so beschlossen wir, diese Ausgabe ganz dem Thema Altruismus zu widmen.
Auch wenn wir sie nicht abschließend beantworten können, so wissen wir doch, dass einige Menschen gerne bereitwillig helfen und unterstützen. Ein Beispiel für solch ein Engagement ist der Tausend Taten e.V. in Jena, bei dem sich Menschen im Bereich der Alten-, Kinder- und Jugendhilfe für andere einsetzen. Warum und wie genau sie sich engagieren, könnt ihr im Interview auf Seite 9 nachlesen. Aber was, wenn Menschen in Schwierigkeiten nicht wollen, dass man ihnen hilft und ihre Probleme nicht auf konventionelle Art und Weise zu lösen sind? In diesem Falle gibt es die Intensive sozialpädagogische Einzelbetreuung, bei der sogenannte jugendliche „Systemsprenger“ zusammen mit einer betreuenden Person auf Reisen gehen. Von dieser Mischung aus Abenteuer und Therapie lest ihr auf Seite 6.
Und was kann man im Alltag für die moralisch weiße Weste tun? Wie wäre es mit ein wenig Umweltschutz? Da liefert unser Umwelt-ABC auf Seite 26 einige Denkanstöße und praktische Tipps für ein Leben mit weniger Plastikmüll, Energiekonsum und einem kleineren CO2-Fußabdruck.
Eine Minderheit zu Verrätern zu stilisieren und in Lager zwangsumzusiedeln, kann man wohl als das Gegenteil von Selbstlosigkeit betrachten. Ab Seite 23 widmen wir uns einem eher unbekannten Kapitel der Weltgeschichte, der Internierung japanisch-stämmiger US-Amerikaner während des Zweiten Weltkrieges, und einem Buch, das diese Geschichte aus sehr persönlicher Sicht darstellt. Bekanntermaßen haben auch in Buchenwald menschenunwürdige Zustände geherrscht; der Ort mahnt uns alle, wohin gruppenbezogene Menschenfeindlichkeit führen kann. Umso wichtiger ist die Frage, wie die Gedenkstätte mit rechten Besuchern und antisemitischen Tendenzen in der Gesellschaft umgeht. Darüber haben wir im Interview (Seite 15) mit dem kommissarischen Stiftungsdirektor gesprochen. Bei Rechtsradikalismus scheinen sich zudem Osten und Westen der Republik stark zu unterscheiden. Aber warum eigentlich? Dieser Frage geht Michael Kraske in seinem Buch Der Riss nach. Den Gastbeitrag des Autors könnt ihr auf Seite 12 lesen.
Zum Schluss ist noch die Frage zu klären, wie man praktischen Altruismus lebt: Wie setzt man sich für andere Menschen effektiv ein, ohne Schaden anzurichten? Vielleicht wäre da der gewaltfreie Protest eine Möglichkeit, welche bereits Tolstoi propagierte. Über den großen Schriftsteller und seine spirituellen Überzeugungen, die wiederum auch Martin Luther King Jr. stark beeinflussten, könnt ihr ab Seite 32 mehr lesen.
Auch wenn euch unser Magazin nicht unbedingt zu besseren Menschen machen kann, zu klügeren werdet ihr durch das Schmökern allemal!
Wir wünschen euch viele spannende Einblicke.
Ausgabe 88:
Der zuverlässigste Weg, in die Zukunft zu sehen, ist das Verstehen der Gegenwart“, meint der US-amerikanische Zukunftsforscher John Naisbitt. Der Beginn eines neuen Jahrzehnts ist schließlich auch der perfekte Moment, sich zu fragen, wo die Welt steht und wo sie sich hinbewegt. Denn unsere Gesellschaft ist beispielsweise in Bezug auf Mobilität, Urbanisierung oder den Umgang mit Rechtsextremismus an einem Punkt angekommen, an dem entscheidende Weichen für die Zukunft gestellt werden müssen. Schon Wilhelm von Humboldt war sich dieser große Verantwortung, die die Gesellschaft gegenüber künftigen Generationen einnimmt, bewusst: „Auch fordert jede Wirkung eine gleich starke Gegenwirkung, jedes Zeugen ein gleich tätiges Empfangen. Die Gegenwart muss daher schon auf die Zukunft vorbereitet sein.“
Wenn wir über die Zukunft sprechen, kommt man nicht an Digitalisierung und dem Klimawandel vorbei, die unser Leben im dritten Jahrzehnt des 21. Jahrhunderts noch mehr beeinflussen werden als in den ersten beiden. Digitalisierung lässt Dinge, die wir lange für utopische Zukunftsmusik hielten, Realität werden. Der Klimawandel stellt eine existentielle Bedrohung für die Menschheit dar. Doch wie wirken diese beiden Megatrends zusammen? Der Frage, ob eine nachhaltige Digitalisierung überhaupt möglich ist, gehen wir auf Seite 17 nach. Viele halten es außerdem für möglich, dass sich Wirtschaftswachstum und Nachhaltigkeit miteinander vereinbaren lassen, dass grüne Innovationen die Wirtschaft ankurbeln und der Umwelt helfen können. Unser Gastbeitrag geht diesem „Entkopplungsmythos“ auf den Grund (Seite 20).
„Ich glaube, die Wahrheit stirbt als erstes im Krieg…“, sagt der Kriegsfotograf Johannes Müller im Interview mit unique über seine ehrenamtliche Arbeit in den Krisengebieten dieser Welt, welche er ab Seite 8 mit eindrucksvollen Bildern illustriert. Er fängt mit seiner Aussage gleich zwei Punkte ein, die uns durch das vergangene Jahrzehnt begleitet haben, denn gerade im Kontext von Fake News wurde viel über Wahrheit und Objektivität gestritten. Wir leben in einem postfaktischen Zeitalter von „Lügenpresse“ und Donald Trump, der ganz nach seiner eigenen Musik zu tanzen scheint. Und die Noten dazu bestehen vornehmlich aus Unwahrheiten. Ist das die Zukunftsmusik? Passend dazu wirft unsere Autorin einen Blick auf die westdeutsche Berichterstattung über den Osten und möchte Stigmatisierung und Stereotypisierung überwinden (Seite 6).
Mit Trugschlüssen räumen wir auch in dem Artikel über das Gift der Frau auf. Denn Menstruationsblut enthält weder mythisches Gift, noch bringt es, wie lange angenommen, Blumen zum Welken (Seite 12).
Die Musik spielt in dieser Ausgabe die US-amerikanische Punkband Anti-Flag, die im Interview mit uns über ihre Meinung zu Donald Trump, seinen Einfluss auf die amerikanische Gesellschaft und über die Punkszene im Allgemeinen spricht (Seite 25). Außerdem bringt uns der Kulturhistoriker Marco Swiniartzki auf Seite 22 die Entwicklung der Metal-Musik näher und erklärt, was sie mit der Globalisierung zu tun hat. Wir wünschen euch einen erkenntnisreichen Blick in die Zukunft.
Ausgabe 87:
„Es geht nicht darum, Grenzen zu verschieben, sondern ihnen den trennenden Charakter für die Menschen zu nehmen“, sagte Richard von Weizsäcker 1985 in seiner Ansprache auf dem 21. Deutschen Evangelischen Kirchentag. Dieser Gedanke ist aber lediglich eine Wunschvorstellung, denn bis heute haben viele Grenzen noch immer einen ausschließenden Charakter. In dieser Ausgabe zeigen wir Euch, wo Grenzen immer noch Länder, Gesellschaften und Kulturen spalten.
Das wohl klassischste Beispiel einer weitreichenden Spaltung sind Konflikte und Kriege. In Afghanistan gehören seit vielen Jahren bewaffnete Konflikte zur Tagesordnung. Besonders betroffen ist dabei vor allem die jüngere Generation. Im Juli wurde der Bericht eines Forschungsprojektes der Universität in Berlin veröffentlicht, der sich mit den Erlebnissen von afghanischen Jugendlichen auseinandersetzt. unique spricht mit Aisha-Nusrat Ahmad, einer Mitarbeiterin des Projekts (Seite 9).
Länder wie die Ukraine und Sri-Lanka sind aktuell vielleicht nicht als Kriegsgebiete zu bezeichnen, sind aber dennoch seit vielen Jahren von Spannungen und Konflikten gezeichnet. Über die Ukraine, ein Land, das vom Zerfall der Sowjetunion, von drei Revolutionen in drei Jahrzehnten und dem schwierigen Verhältnis zu Russland geprägt ist, könnt Ihr auf Seite 6 mehr erfahren. Mit welchen Problemen Sri Lanka nach fast 26 Jahren Bürgerkrieg konfrontiert ist und mit welchen Mitteln versucht wird, diese zu bewältigen, lest Ihr auf Seite 13.
Grenzen sind nicht nur erlebbar, sondern können auch für das menschliche Auge sichtbar sein – teilweise sogar aus dem All. Wie künstliches Licht die Grenzen zwischen Ländern – oder auch zwischen Krieg und Frieden – deutlich machen kann, ist in den eindrucksvollen Nachtaufnahmen auf Seite 18 zu sehen.
Ein Versuch sich abzugrenzen und somit eine Identifikationsgrundlage zu schaffen, wurde in den 70er Jahren von Teenagern und jungen Erwachsenen unternommen. Aus dieser musikalisch geprägten Rebellion gegen gesellschaftliche Zwänge entstand der Punk. Auf Seite 20 zeichnen wir ein umfassendes Bild dieser Kultur, von den Wurzeln bis hin zu ihrer Bedeutung für die heutige Zeit.
Eine Figur, die ganz anders denkt als alle anderen, sich keiner Gruppe zugehörig fühlt und in ihrer eigenen Welt lebt, ist Sherlock Holmes. Eine kleine Charakterstudie des berühmtesten fiktiven Detektivs aller Zeiten, seine literarischen und historischen Ursprünge sowie seine Auswirkungen auf Figuren des 20. und 21. Jahrhunderts findet Ihr auf Seite 28.
Kulturen, Gesellschaften und ganze Nationen spalten sich aus den unterschiedlichsten Gründen. Diese wieder zu vereinen, ist oft ein schwerer, langwieriger Prozess. Wir wünschen Euch viele interessante Einblicke.
Ausgabe 86:
Nach dem Exit ein Neuanfang? Nach dem Ausstieg ein Einstieg? Mit diesen Fragen sehen sich viele Menschen konfrontiert: Sei es der Ausstieg aus dem Beruf, aus dem gewohnten Umfeld oder sogar aus dem bisherigen Leben. Viele Aussteiger waren damals und sind auch heute noch dazu gezwungen, eine Antwort auf diese Fragen zu finden. Sie alle stehen vor einer sehr großen Herausforderung, für die es keinen idealen Ausweg gibt.
Vor ähnlichen Schwierigkeiten standen auch die Frauen, die von ihren eigenen Töchtern liebevoll als „Mama Superstar“ bezeichnet werden. Sie sind gewöhnliche Menschen, die den Irak, Indien, Korea und andere Heimatländer verlassen haben, um aus ihrem alten Leben auszusteigen. Ihre Lebensgeschichten sind beeindruckend, weil sie sich von konventionellen Rollenbildern abgewandt haben und den Mut gefasst haben, zu neuen Ufern aufzubrechen. Über den Ausstieg und Neuanfang der Mütter erzählen ihre Töchter in dem Band, den wir euch auf Seite 6 vorstellen. Auch Daria Bogdanska hat einen Neuanfang gewagt: Die gebürtige Polin ging nach Schweden, um dort Kunst zu studieren. In ihrem Comic Von Unten verarbeitete sie ihre Erfahrungen mit prekären Aushilfsjobs. Wir sprachen mit ihr über die Entstehung ihres Comics und die Arbeitsbedingungen von Migranten in Schweden (Seite 17).
Im Gegensatz zu den elf Migranten-Mamas und Daria Bogdanska, die ihr altes Leben vollständig hinter sich gelassen haben, ist es für viele schon genug, einfach mal für eine begrenzte Zeit aus ihrem Alltag rauszukommen, etwas von der Welt zu sehen, um dann mit neuen Erfahrungen in ihr bisheriges Leben zurückzukehren. Studenten können dies bei einem Auslandssemester erleben. Eine unserer Redakteurinnen hat letztes Jahr ein solches in Estland absolviert. 9¾ ihrer Beobachtungen und Erfahrungen über das hierzulande oftmals unbekannte baltische Land hat sie für euch festgehalten (Seite 8).
Manche Menschen steigen auch aus ihrem Leben aus, ohne irgendwo wieder einsteigen zu wollen. Sie wollen sich von der Gesellschaft abzuwenden. Das Motiv des Aussteigers ist für die Literatur schon seit langer Zeit sehr fruchtbar. Der Aussteiger flieht in die Natur, um sich selbst zu finden, frei zu sein, zu heilen, sich etwas zu beweisen oder die Gesellschaft radikal zu kritisieren. Auf Seite 23 präsentieren wir euch Henry D. Thoreaus Walden, Jon Krakauers Into The Wild und Cheryl Strayeds Wild.
All diese Aussteiger befinden sich in einer Situation, die nicht mehr geradeaus führt, sondern in einer Sackgasse endet. Ausstieg kann aber nicht nur im Zusammenhang mit Menschen, sondern auch mit erneuerbaren Energien stehen: diese lösen nach und nach die konventionelle Stromerzeugung ab, um dem Klimawandel zu begegnen. Welche konkreten technologischen und gesellschaftlichen Herausforderungen und Dilemmata bei der Umsetzung anstehen, könnt ihr in unserem Beitrag ab Seite 11 lesen.
Der Entschluss auszusteigen, ebenso wie der Ausstieg selbst, sind immer mit enormen Schwierigkeiten verbunden. Jeder Mensch geht damit anders um, bewältigt die Schwierigkeiten auf seine Weise. Eins haben aber alle gemeinsam: Jeder, dem ein Aus- und danach ein Wiedereinstieg gelungen ist, hat einen steinigen Weg hinter sich und kann eine Inspiration für andere sein. Bei der Lektüre dieses Hefts wünschen wir viel Vergnügen.
Ausgabe 85:

Mit dem Tod habe ich nichts zu schaffen. Bin ich, ist er nicht. Ist er, bin ich nicht“, hat schon Epikur vor über 2000 Jahren gesagt. Kaum ein Thema prägt uns so sehr und wird doch gleichzeitig aus unseren Gedanken und Gesprächen so lange wie möglich verbannt, wie der Tod und die Frage nach einem Leben nach dem Tod.
Das Bild von der Seele, die in den Himmel oder die Hölle wandert, die Reinkarnation in verschiedene Lebewesen oder der Eintritt ins Paradies mit unzähligen Jungfrauen – Vorstellungen von dem Leben nach dem Tod gibt es viele. Besonders prägend für das europäische Bild der Hölle, des Fegefeuers und des Paradieses war Dante Alighieris Göttliche Komödie (1307-1321): eine gleichermaßen religiöse, philosophische und politische Dichtung, aus der Ihr einen Auszug auf Seite 27 lesen könnt. Vorstellungen des Jenseits, helfen dabei, mit der Angst vor dieser unvermeidlichen Tatsache umzugehen: dass wir alle eines Tages das Zeitliche segnen, über den Jordan gehen, den Löffel abgeben – wie man das auch immer bezeichnet. Über eben solche Umschreibungen und Metaphern des Sterbens in der deutschen, englischen und französischen Sprache erfahrt Ihr mehr in der Sprachkolumne von Prof. Dr. Thomas Honegger (Seite 29).
Vielen weniger geläufig dürfte der Begriff der Thanatosoziologie sein – die soziologische Beschäftigung mit dem Ableben. Unser Gastautor Prof. Dr. Klaus Feldmann gibt ab Seite 16 einen einführenden Überblick über verschiedene Formen des Sterbens – physich, psychisch und sozial.
Die Vorstellung nach Unsterblichkeit prägt nicht nur unsere Träume, sondern beschäftigt seit Jahrhunderten auch Forscher. Die Kryobiologie bildet einen modernen Versuch, das Leben auf Erden zu verlängern, oder zumindest Zellen zu präservieren: Der Anatom Prof. Dr. Klaus Sames erläutert in seinem Meinungsbeitrag (Seite 8 ) die Grenzen und Chancen dieser Technik. Dem entgegen beschreibt unsere Gastautorin, Zellbiologin Dr. Anna Müllner – ab Seite 18 – die Prozesse der Alterung und erklärt, warum aus rein biologischer Sicht bisher niemandem der Durchbruch zur Untersterblichkeit gelingen konnte und wohl auch niemals gelingen wird (und sollte).
Körper sterben, aber Kunstwerke bestehen weiter. Die russische Bewegung des Kosmismus prophezeite die Wiederauferstehung aller Menschen – unter anderem mit den Mitteln der Kunst. Mehr über diese eigenartige und heute kaum bekannte Bewegung erfahrt Ihr in unserem Fotoessay auf Seite 22. Heute fast so unbekannt sind die sogenannten „lacrima movies“: eine kurzzeitige, aber in den 1970er Jahren sehr erfolgreiche Welle italienischer Filmmelodramen, in denen kleine Kinder in unglücklichen Familien an Krankheiten sterben (Seite 24). So traurig die „lacrima movies“ sind – es ist tröstlich, sich zu vergegenwärtigen, dass sie „nur“ Filme sind. Doch leider sterben Kinder auch im wahren Leben, manche kurz nach der Geburt oder im Mutterleib. Die Hebamme Elisabeth Blecks betreut Eltern von Sternenkindern und spricht mit unique auf Seite 10 über ihren persönlichen Hintergrund, gemeinsames Weinen mit Eltern und die zentrale Bedeutung von Zeit für die Trauerbewältigung.
Auch wenn wir euch mit dieser Ausgabe vielleicht nicht die Angst vor dem Tag X nehmen können, hoffen wir doch, dass ihr einige neue Perspektiven auf dieses Thema gewinnt. Eine erkenntnisreiche Lektüre wünscht euch eure Redaktion!
Ausgabe 84:
2018 ist vorbei, die Studenten sammeln sich vollgefressen nach den Festtagen wieder in den Vorlesungssälen und überall geht der Gedanke um: Endlich war es das. Ja, 2018 war sicherlich kein gutes Jahr. Die politische Stimmung hat sich in vielen Ländern hochgeschaukelt, ein Skandal jagte den nächsten und so war man quasi permanent am Kopfschütteln. Dabei machten sich auch große Vorbilder bemerkbar, wie zuletzt die schwedische Schülerin Greta Thunberg mit ihrer emotionalen Rede beim EU-Klimagipfel, oder die frühere First Lady Michelle Obama, die mit ihrer Autobiographie Einblicke in ihre damalige Lebenswelt gewährt.
Es war in erster Linie ein großes Jahr für die Frauen – mit der Aufarbeitung früherer Skandale, der Enttabuisierung von Sexismusdebatten im Showgeschäft oder von Schwangerschaftsabbrüchen (etwa in Irland) und der daraus resultierenden körperlichen Selbstbestimmung.
Großes Engagement bewies auch Tawakkol Karman. Geboren im Jemen, setzte sie sich erst als Reporterin für die Abschaffung von Kinderehen ein und organisierte später Demonstrationen und Protestaktionen. Unser Interview mit Karman findet ihr auf Seite 9. Für ihr Engagement gewann sie 2011 den Friedensnobelpreis. Diese Auszeichnungen zeigen aber auch, dass es auf der Welt noch eine ganze Menge zu tun gibt, der Weg zur Gleichstellung der Geschlechter ist noch lang.
Das zeigt sich auch in unserem Duell der Nebenentdecker – Wissenschaftler, die die gleiche Entdeckung machten, jedoch nicht immer dasselbe Ausmaß an Anerkennung erhielten. Fakt ist, dass die ein oder andere Frau ihren männlichen Arbeitskollegen schon eine Nasenlänge voraus war (S. 12).
2018 war zusätzlich auch das Jahr der großen Flüchtlingsdebatten. Wie sich geflüchtete Frauen hier in Deutschland zurecht finden und was unsere hauseigenen Unisportkurse damit zu tun haben, erfahrt ihr auf den Seiten 6 und 7. Die Kriege, vor denen die Menschen flüchten, fordern aber nicht nur menschliche Opfer. Oft leidet auch die Kultur des Landes darunter, weil große künstlerische Errungenschaften zerstört, beschädigt oder gestohlen werden. Im Zweiten Weltkrieg besonders von Kunstzerstörungen und vor allem vom Kunstraub betroffen war Polen. Die frühere polnische Ministerin für Kultur und Nationales Erbe, Frau Prof. Dr. Małgorzata Omilanowska, spricht mit uns über die Rückgabe von Raubkunst in der Jetztzeit und ihre juristischen und politischen Grenzen (S. 16).
Wer schon einmal eine Hausarbeit geschrieben hat, kennt sicher das Gefühl einer Schreibblockade. Das betrifft nicht nur Studenten, sondern auch große Schriftsteller – zum Beispiel Franz Kafka. Über die Genese von Kafkas Novelle Das Urteil und seine Arbeit als Autor zwischen quälenden Selbstzweifeln und tranceartigem Schaffensrausch könnt ihr auf Seite 20 lesen.
2019 hat begonnen. Mit dieser Ausgabe starten wir mit euch ins neue Jahr und blicken gespannt darauf, was es für Geschichten schreiben wird!
Ausgabe 83:
Zur Herbstzeit, als sich die Blätter golden färbten und sich die Wolken langsam wie Watte über die lichte Sonne legten, war einmal eine kleine, fleißige Redaktion. Sie arbeitete von früh bis spät ohne Ruh, denn das neue Heft sollte doch pünktlich fertig werden. Über Märchen sollte es sein – solche, die ein jeder kennt, jedoch von Familie zu Familie stets unterschiedlich erzählt werden.
Während draußen die Ochsen mit den Pflügen übers Feld zogen und die jungen Lämmlein sich vor den bösen Wölfen versteckten, zerbrachen sich die Redakteure drinnen die Köpfe darüber, welche Erzählungen wohl für die Leser in ihren trauten Studiosus-Hütten aufregend und spannend wären. Geschützt im alten Haus auf der Mauer, das jedem Windstoß, jedem Husten und Prusten widerstand, kamen ihnen die Ideen. Das Motto „Und sie lebten glücklich bis an ihr Lebensende“ ist jedermann bekannt, das Herz der Prinzessin immer das Ziel, und der Sieg über das Böse stets gewiss. Wie Männlein und Weiblein miteinander im Märchen umgehen, war stets eng mit zeitgenössischen Normen und Regeln verknüpft. Doch wie hat sich das Verhältnis der Geschlechter in Märchen über die Jahre(szeiten) geändert? Unsere Erzählung dazu findet ihr auf Seite 11.
Wer zwischen den Märchenstunden beherzt in einen Thüringer Kloß beißt, wird auch das Märchen der Frau Holle kennen. Frau Holle kommt aus Thüringen und aus dem Hessischen und hat beileibe nicht nur immer Klöße gemacht. Über ihre bewegte Vergangenheit, in der sie nicht allzeits nur eine Gute war, lest ihr auf Seite 19.
Heftchen, Heftchen in meiner Hand, welches ist das schönste Fabelwesen im ganzen Land? Die kleine, fleißige Redaktion weiß das nicht, hat sich aber trotzdem auf eine große Suche nach fast völlig vergessenen Kreaturen im Hohen Norden, Nahen Osten, Fernen Osten sowie jenseits des großen Teichs begeben und einige von ihnen für euch in einem Alphabet zusammengetragen (S. 16).
In einem kleinen Land weit im Südosten schrieb einmal ein Dichter mit Namen Bogomil Gjuzel über Drachen und Narren. Damit erzählte er nicht nur von fantastischen Fabelwesen aus fernen Zeiten, sondern auch von Problemen, Nöten und Alltag seines Landes. Eine seiner Erzählungen in Versform findet ihr auf Mazedonisch sowie in einer deutschen Übertragung auf Seite 22.
Neugierig? Dann macht es Euch am warmen Kamin gemütlich, zieht den roten Mantel aus, stellt die Spindel beiseite, sperrt Eure bösen Stiefmütter und Stiefschwestern aus und taucht in unser neues Heft ein – bis es dann irgendwann vielleicht heißt: Und sie lasen glücklich bis ans Ende dieser Ausgabe…
Ausgabe 82:
Schon viele Jahre vor Christus prophezeite Jesaja: „Denn siehe, ich will einen neuen Himmel und eine neue Erde schaffen, daß man der vorigen nicht gedenken wird noch zu Herzen nehmen“ (Jesaja 65;17). Heute, im 21. Jahrhundert, scheint der Mensch keinen Gott mehr zu brauchen und erschafft sich seine Erde – zugegeben nicht in sieben Tagen – einfach selbst. Oder besser gesagt: Er erzählt sie neu. Das „Anthropozän“, das wir auf Seite 5 kurz einführen, bezeichnet die Vorstellung, dass massiver menschlicher Einfluss eine neue geologische Epoche eingeläutet hat. Dieses Narrativ nimmt in wissenschaftlich-publizistischen Debatten seit den 2000er Jahren eine bedeutende Rolle ein: Für die „Erfinder“ des Begriffs selbst, ebenso wie für die Verteidiger und seine Kritiker. Mit der medialen Wirksamkeit des Anthropozäns und der Frage, wie gut sich Wissenschaft und PR in der Debatte trennen lassen, beschäftigt sich unser Artikel ab Seite 23. Einer der zentralen Diskussionsakteure ist Christian Schwägerl: Im Interview auf Seite 8 spricht der Wissenschafts- und Umweltjournalist über das Selbstverständnis von Wissenschaft und Forschung sowie über die Perspektiven des Wissenschaftsjournalismus. Das Anthropozän ist auch Ausdruck eines stark wachsenden Bewusstseins für Umweltprobleme und -zerstörungen. Das sowjetische Regime setzte sich in seinen ambitionierten, gar größenwahnsinnigen Großbauprojekten über solche Bedenken hinweg. Über ein Vorhaben, ganze Flüsse über tausende Kilometer umzuleiten, was möglicherweise Klima und Fauna im Polarkreis und in Westsibirien geändert hätte, lest ihr auf Seite 19. Obwohl dieses Projekt aus politischen und finanziellen Gründen scheiterte, sind Umweltzerstörungen anderswo natürlich Realität – zum Beispiel in Form großflächiger Waldrodungen. Zwar versucht der Mensch mittlerweile Teile wieder aufzuforsten, jedoch lassen sich dadurch nicht alle Probleme lösen. Die Jenaer Geografin Christiane Schmullius versucht mithilfe moderner Satellitenbilder, diese Rodungen zu dokumentieren und zu prognostizieren, wie viel Wald noch abgeholzt werden könnte, bis uns schlussendlich die Luft zum Atmen ausgehen wird (Seite 11). Einen künstlerischen Zugang zur Dokumentation von Naturzerstörung findet die Künstlerin Betty Beier. Über ihre Spurensammlungen und ihre Kunstobjekte „Erdschollen“ lest ihr ab Seite 20. Nachhaltige, technologische Lösungsvorschläge für die Schattenseiten des Anthropozäns finden sich viele: Von modernen Müllfilteranlagen auf dem Meer über plastikzersetzende Bakterien bis zum CO2-Sauger. Einige der interessantesten Ansätze findet ihr in einer Zusammenstellung ab Seite 14. Aber nicht nur Forscher, sondern auch Unternehmer und Konsumenten können einen kleinen Beitrag dazu leisten, den menschlichen Fußabdruck auf dem Planeten verträglicher zu gestalten: Über Strategien der Plastikmüllvermeidung und den neuen Trend zum unverpackten Einkaufen in der Welt und im Speziellen in Jena lest ihr ab S. 6.
Diese Ausgabe entstand in Zusammenarbeit mit dem Seminar „Grundlagen des Wissenschaftsjournalismus am Beispiel des Anthropozäns“ am Institut für Germanistische Literaturwissenschaft, das im Wintersemester 2017 an der Universität Jena gehalten wurde. Das Interview mit Christian Schwägerl sowie drei Artikel entstanden im Rahmen dieser Lehrveranstaltung unter der Leitung von PD Dr. Peter Braun. Ihm und den Seminarteilnehmerinnen, die ihren Abschlusstext zur Verfügung gestellt haben, danken wir herzlich für die freundliche Unterstützung bei der Entstehung dieser Ausgabe. Bei der unique erschaffen wir nicht die Welt neu, dafür aber regelmäßig neue Ausgaben. Bei der Lektüre dieses Hefts wünschen wir viel Vergnügen.
Ausgabe 81:

Was steckt hinter der Fassade? Dieser Frage widmet sich der französische Fotokünstler Zacharie Gaudrillot-Roy in seiner Bilderserie Façades, von der ein Motiv auf unserem Titelblatt zu sehen ist. Mit demselben Problem beschäftigen wir uns als Medienschaffende immer wieder: Was sehen wir? Was ist „echt“ und was „wahr“? Was können uns Täuschungen und Illusionen über unsere Welt vermitteln? Kann etwas, das gestellt oder nur gespielt ist, auch „echt“ sein?
Simulationen, also „falsche“, „nachgespielte“ Handlungsmuster und Situationen, sind in der Wissenschaft eine gängige Methode zur Erkenntnisgewinnung. Die Geophysikerin Christiane Heinicke hat an dem NASA-Projekt HI-SEAS teilgenommen. Ein Jahr lang stellte sie zusammen mit fünf anderen Crewmitgliedern auf dem hawaiianischen Vulkan Mauna Loa die Situation einer Mars-Mission nach. Dabei lag das Hauptaugenmerk nicht auf der technischen, sondern auf der zwischenmenschlichen Umsetzung: Könnten Menschen auf dem Mars über Monate hinweg auf engstem, reglementiertem Raum zusammenleben? Im Gespräch mit unique berichtet die 32-Jährige, wie die wissenschaftlich simulierte Mars-Mission ihr Stress-management und ihre Wahrnehmung der „echten“ Welt verändert hat (Seite 13).
Ebenfalls simuliert, aber bei Forschern eher von umstrittenem Nutzen, sind historische Reenactments, bei denen „Hobbyhistoriker“ unter anderem bedeutende historische Schlachten nachstellen. Als sinnlich greifbares Erleben von Geschichte und vor allem als Event sind diese Veranstaltungen sehr beliebt. Im Interview auf Seite 9 erklärt die Kulturwissenschaftlerin Juliane Tomann, welche Chancen und Grenzen Reenactments haben können.
Einen etwas anderen Ansatz verfolgen Teilnehmer bei „Live Action Role Plays“ (kurz: Larps): Hier finden sich Erwachsene aus ganz Europa zusammen, um eigene, fiktive Geschichten zu spielen und zu durchleben. Unsere Redakteurin hat am Nordic Larp NEXUS-6 bei Paris teilgenommen (Seite 6), bei dem die Teilnehmer 24 Stunden lang Soldaten einer fiktiven Diktatur verkörpert haben. Nicht Spektakel, sondern das Nachempfinden des Lebens in einer Extremsituation stand im Vordergrund – und die oft unangenehme, aber sehr erkenntnisreiche Erforschung der eigenen „versteckten Potentiale“ in Sachen Gewalt, Rassismus und antisoziales Verhalten.
Kurz nach Sendebeginn Ende der 1990er stand das Fersehformat Big Brother wegen Voyeurismus und Sensationsgier in der Kritik, obwohl es den Zuschauern „mehr Authentizität“ versprach. In ihrem Gastbeitrag auf Seite 24 untersucht die Kunsthistorikerin Elisabeth Fritz, wie das „Echte“ im eigentlich hochgradig künstlichen Kontext der Medienproduktion nachgestellt wird: von den Anfängen mit Experimental- und Avantgardefilmen der 1930er bis 1960er Jahre bis zu Fernsehsendungen mit versteckter Kamera und den ersten Schritten in Richtung Reality-TV. Fiktive Realitäten gibt es aber natürlich nicht nur auf dem kleinen Bildschirm, sondern auch auf der großen Leinwand: Das Kino, das ist 24 mal die Wahrheit pro Sekunde – das vielzitierte Bonmot des Filmemachers Jean-Luc Godard lädt dazu ein zu erkunden, wie Kino ganz eigene Interpretationen des „wahren“ und „echten“ Lebens hervorgebracht hat und dabei auch das „echte“ Leben außerhalb des Lichtspielhauses hinterfragt. Über verliebte Träumer, obsessive Künstler, simulierte Parallelwelten und bedrohliche Untote lest ihr in unserer Rubrik „10 Filme“ auf Seite 26.
Was steckt also hinter dieser Seite? Wir laden euch herzlich dazu ein, dies blätternd zu erforschen und wünschen viel Spaß bei der Lektüre unserer 81. Ausgabe.
Ausgabe 80:
Konfuzius sagt: „Nur wer mit dem Strom schwimmt, wird das Meer erreichen.“ Wie richtig – und doch ist die Welt mehr als nur Meer. Trotz innerer und äußerer Widerstände drängt es viele Menschen nicht auf direktem Wege zum Ozean: Sie erkunden lieber Nebenflüsse und unentdeckte Bäche. Sich aus dem Hauptstrom, der Mainstream-Mehrheitsgesellschaft, zurückzuziehen, ist heutzutage leichter und zugleich schwieriger als zu Konfuzius‘ Zeiten oder auch noch vor 30 bis 50 Jahren. Reisefreiheit, Internet, vielfältige Konsummöglichkeiten und die relative Akzeptanz liberaler Wertvorstellungen sind Fluch und Segen zugleich, denn nebst Freiheiten schaffen sie auch Erwartungen und Erwartungsdruck. Wer davon abschalten möchte, kann sich zum Beispiel in ein thailändisches Schweigekloster zurückziehen und sich dort einem intensiven Meditationsprogramm unterziehen, um seine inneren Energien zum Fließen zu bringen – unsere Redakteurin berichtet auf Seite 6 von ihren Erfahrungen.
Alternativen zum Mainstream muss man aber nicht unbedingt nur im Fernen Osten suchen: Man findet sie auch auf Gemüsefeldern in der Nähe von Jena. Auf dem biologischen SoLaWi-Hof Diestels Sonnengarten wohnen und wirtschaften zwei Gärtner und versorgen solidarisch organisiert Abnehmer aus der Umgebung. Mit dem Wesentlichen, nämlich „Essen und Wohnen“, kann man durchaus glücklich sein, wie ihr in unserem Einblick auf Seite 10 lesen könnt – beim IWF und der Weltbank wird man damit allerdings nicht punkten. Deren Bewertungskriterien und Fixierung auf das Bruttoinlandsprodukt führen dazu, dass stabile Entwicklungsländer mit funktionierenden Kleinwirtschaften künstlich „arm gerechnet“ werden, so der Entwicklungsökonom Alexander Dill in seinem aktuellen Buch Die Welt neu bewerten. Die Rezension dazu lest ihr auf Seite 17.
Wer Nebenflüsse unabhängig von vorherrschenden Deutungsmustern in einer Diktatur sucht, hat es besonders schwer. Das merkte der Wahljenaer Schriftsteller Udo Scheer in den 1970er Jahren, als er sich mit anderen jungen Autoren im nichtstaatlichen Arbeitskreis Literatur und Lyrik engagierte. Über literarische Subkulturen in der DDR und Jena sowie offene und subtile Zensurformen lest ihr im Interview auf Seite 30. Noch wesentlich elementarer ist die Rebellion junger Iranerinnen und Iraner gegen das Mullah-Regime und seine restriktive Ehe- und Sexualpolitik. Ein französisches Journalistenpaar und ein Zeichner erzählen in einem Comic von der Suche nach Liebe und von Oasen der Intimität im Iran (Seite 27).
À propos Gewässer: „Das Englische“ gilt heute als sprachlicher „Mainstream“. Das war nicht immer so; vielmehr bildete sich „das Englische“ aus mehreren „Wildbächen“, „Haupt- und Nebenflüssen“ sowie „Zuläufen“. Über die (wenn man so will: hydrologische) Vielfalt der englischen Sprache(n) lest ihr in unserer Sprachkolumne auf Seite 33. Für seinen nunmehr 30. sowie für alle vorangegangenen und hoffentlich künftigen Beiträge möchten wir Professor Dr. Thomas Honegger an dieser Stelle herzlichst danken.
Ob mitten im reißenden Strom oder auf eurer eigenen kleinen Scholle: Wir wünschen allen neuen und alteingesessenen Studis und Lesern ein erfolgreiches Wintersemester und eine interessante Lektüre unserer 80. Ausgabe.
Ausgabe 79:
Als Medienschaffender hat man es dieser Tage nicht leicht: ständig kritische Kommentare löschen, in den Artikeln Daten beschönigen, unerwünschte Fakten vertuschen. Und dann noch der wöchentliche Rapport in Berlin, wo alle Medien vom kleinen Studentenmagazin bis zur großen Tageszeitung antanzen müssen, um sich von der Kanzlerin persönlich die Berichterstattung der nächsten Woche in den Block diktieren zu lassen! Die Kollegen vom „Staatsrundfunk“ haben’s gut – die gehen wenigstens mit Koffern voller Steuergelder nach Hause. Aber im Ernst: Der Journalismus steht nicht gut da. Auf der einen Seite die von einschlägiger Seite geäußerten Vorwürfe der „Lügenpresse“, die sich teils in aggressiven Drohungen präsentieren, teils aber auch breite Resonanz finden. Auf der anderen Seite der Wunsch vieler Rezipienten, hochqualitative Inhalte nicht nur online und sofort, sondern bitte auch kostenfrei zu erhalten. Wie verhält man sich gegenüber diesen Problemen? Darüber haben wir mit dem Bundesvorsitzenden des Deutschen Journalistenverbandes Frank Überall gesprochen (S. 22).
Einseitigkeit gehört zu den gängigen Vorwürfen, die an die Medien gerichtet werden. Wie kann man also zum Beispiel über die aktuelle Krise in der Ukraine und die diplomatischen Verwerfungen zwischen der Europäischen Union und Russland berichten, ohne „einseitig“ zu werden? Dieser Frage haben wir uns gestellt, indem wir uns mit dem russischen Botschaftsrat Mikhail Grabar unterhalten haben – und anschließend zwei deutsche Osteuropaexperten die mediale Darstellung des Konflikts einordnen ließen (S. 11).
Unmittelbarer als jedes geschriebene oder gesprochene Wort wirken Bilder. Wie über politische Krisengebiete berichtet wird, darauf hat auch die Arbeit von Fotojournalisten einen gewissen Einfluss. Mit dem Medienwissenschaftler Felix Koltermann sprachen wir über Objektivität und Authentizität, den Handlungsspielraum des einzelnen Fotojournalisten und über den politischen Missbrauch von Fotos aus Kriegsgebieten (S. 29). Die Macht der (bewegten) Bilder machen sich Staatsführungen mitunter auch in Form von filmischer Propaganda zu Nutzen, um Feindbilder zu transportieren oder die eigene Machtstellung zu festigen. Auf Seite 27 zeigen wir das am Beispiel Irans.
Nicht nur staatliche Akteure oder sogenannte besorgte Bürger versuchen, Einfluss auf mediale Berichterstattung zu nehmen – auch die freie Wirtschaft versucht immer wieder, direkt oder indirekt auf journalistische Inhalte einzuwirken. Aufmerksame Leser der unique werden gemerkt haben, dass in jedem Heft werbefinanzierte Teile zu finden sind – deutlich als „Anzeige“ markiert. Bei manchen Zeitschriften und Magazinen, besonders im Bereich Lifestyle und Gesundheit, ist eine solche Markierung nicht selbstverständlich: Ein PR-Journalist gibt uns auf Seite 10 persönliche Eindrücke aus seiner Arbeit.
Wir hoffen also, dass nach Lektüre dieses Hefts die Urteile nicht „Lügenpresse“, „gekauft“ oder „einseitig“ lauten werden – und wünschen interessante Einblicke.
Ausgabe 78:

„Der erste, der ein Stück Land einzäunte und sagte ‚Dies gehört mir‘ und der Leute fand, die einfältig genug waren, ihm zu glauben, war der eigentliche Begründer der zivilen Gesellschaft.“ Die Beschäftigung damit, wer sich dies- oder jenseits von „Zäunen“ befindet oder befinden soll und wer gegebenenfalls außerhalb des „Stück Landes“ verwiesen wird, ist auch heute, über 250 Jahre nach Jean-Jacques Rousseaus Ausspruch, noch sehr aktuell.
Sich abzuschotten hat gerade Konjunktur. Die EU, geschaffen als Ort, innerhalb dessen sich Angehörige frei bewegen können, hat sich in den letzten Jahren immer mehr zu einer abgeschotteten Insel entwickelt – eine Friedensinsel, die ironischerweise zugleich gerade die Menschen fernhalten möchte, die vor Kriegen, Repressionen und Elend flüchten. Wer es lebendig über den natürlichen „Zaun“ – das Mittelmeer – schafft, wird noch lange nicht Teil der europäischen Gesellschaft: Der Zugang zu Europa wird für Flüchtlinge mittlerweile auch mit biologischen Mitteln kontrolliert: Medizinische Methoden zur Altersbestimmung und DNA-Tests sollen Volljährigkeit und Familienzugehörigkeit bestimmen. Über die Ausübung und Folgen eines solchen „biologischen Grenzregimes“ lest ihr im Interview mit dem finnischen Soziologen Ilpo Helen (Seite 17) und in einem Meinungsbeitrag auf Seite 16.
Technik ist bekanntermaßen nicht nur ein Mittel der Abschottung, sondern dient häufig zur Öffnung: „Weltliche Verführungen“, übertragen durch Bücher, Radio, TV und vor allem das Internet, bringen immer mehr junge israelische Ultraorthodoxe dazu, sich von ihrer streng abgeschotteten, religiösen Lebenswelt abzuwenden. Über die Schwierigkeiten der sogenannten XOs (Ex-Orthodoxen), sich in die säkulare, demokratische Gesellschaft Israels zu integrieren, lest ihr auf Seite 6.
Eine säkulare, demokratische Gesellschaft gibt es in Iran zwar nicht – aber auch dort leben viele Menschen, die sich mithilfe des Internets von Beschränkungen und Ausgrenzungen befreien wollen. Über die anstehende iranische Präsidentschaftswahl, die Rolle der sozialen Medien im Land und die Wahrnehmung von Außenstimmen (meist aus dem Westen) sprachen wir mit der Journalistin und Autorin Charlotte Wiedemann (Seite 12).
Nicht erst seit Donald Trumps Drohung, eine Mauer zwischen den USA und Mexiko bauen zu wollen, beschäftigen sich Künstler und Kreative mit Mechanismen der Abschottung, Ausgrenzung und Isolation. Über zehn dieser Ergebnisse – von Frida Kahlo bis Christo, vom Fotoprojekt bis zum Computerspiel – lest ihr auf Seite 24.
Der eingangs zitierte Rousseau schrieb übrigens auch, dass viele Kriege, Verbrechen und Morde verhindert worden wären, wenn bloß jemand die Zaunpfähle ausgerissen hätte. Auch wenn kein unique-Redakteur aufbrechen wird, um in Jenaer Schrebergärten Zaunpfähle auszureißen (zumindest nicht im Namen der Redaktion), so hoffen wir, dass diese Ausgabe euren Blick für Prozesse der Abschottung (und auch ihrer Überwindung) schärft.
Ausgabe 77:

„I hope I die before I get old”, sangen The Who in ihrem berühmten Hit My Generation. In vier Strophen und knapp drei Minuten drückten sie jugendliche Rebellion gegen die ältere Generation der Spießer aus – drei Jahre vor 1968, als die Besungenen in der ganzen westlichen Welt gegen die Eltern rebellierten. Auch jenseits des Eisernen Vorhangs rumorte es: in Polen, der Tschechoslowakei – und weniger offensichtlich in der Sowjetunion. Hier begann die „Generation der 60er Jahre“ sich intellektuell und politisch vom Regime zu entfernen. Die meisten dieser sogenannten „Schestidesjatniki“, über die ihr ab Seite 13 lest, starben nicht, bevor sie alt wurden, sahen aber ihren Staat im Zuge von Gorbatschows Reformpolitik sterben.
Nach dem Ende der Sowjetunion suchten die Nachfolgerepubliken ihren eigenen politischen und wirtschaftlichen Weg – ohne, dass Generationenkonflikte verschwanden. Georgien ging den Weg der Westorientierung und wandte sich vom Russischen ab, das in der Sowjetzeit prägend war. Dies, wie auch die Geschichtspolitik trennt die jungen von den alten Georgiern – worüber ihr ab Seite 9 mehr erfahrt. Vor der jugendlichen Rebellion kommt zuerst die Kindheit. Die Vorstellungen davon, welche Rolle Kinder in einer Gesellschaft spielen sollen und dürfen, sind einem ständigen Wandel unterworfen. Im Interview mit der Historikerin Sandra Leinert und der Museumskuratorin Teresa Thieme (Seite 16) sprachen wir über Kindheit und Erziehung in Deutschland um 1900 und die Bedeutung von Klassenzugehörigkeit und militaristischer Indoktrination.
Generationenkonflikte haben natürlich Künstler auch bereits vor The Who als fruchtbares Subjekt für ihre Werke entdeckt: Kinder, die ihre eigenen Eltern ermorden; Eltern, die ganze Schulklassen dem Tod freigeben; aber auch intergenerationelle Gemeinschaften von Trinkern und Revolverhelden sind der Stoff, aus dem Generationenbeziehungen auf Zelluloid entstehen – eine Auswahl von zehn Filmen findet ihr ab Seite 22. Noch nicht für das Kino adaptiert wurde bislang Douglas Couplands legendärer Roman Generation X. Dieser wurde – ganz entgegen den Intentionen Couplands – für die 1990er Jahre zum prägenden Schlagwort und schließlich zur trivialisierten Phrase, wie unser klassiquer auf Seite 26 beschreibt.
Ein Vorreiter ganz anderer Art, der Dichter Marió de Andrade, Begründer des Modernismus in der brasilianischen Literatur, schrieb ambivalente Verse über seine Mutter. Das Gedicht „Mãe“ sowie mehr zu ihm und seiner Lyrik findet ihr auf Seite 24. 2016 beging übrigens die unique heimlich, still und leise ihr fünfzehnjähriges Bestehen. In der Redaktion hat sich, glücklicherweise ganz ohne Blutvergießen, ohne dramatischer Konflikte und – leider? – ohne weltpolitische Aufmerksamkeit, ein Generationenwechsel vollzogen: Alteingesessene haben sich ganz oder teilweise zurückgezogen, um neuen Schreibern, Layoutern und Helfern eine Chance zu geben. Letztere haben bereits einen beträchtlichen Beitrag zu dieser Ausgabe geleistet. In diesem Sinne wünschen sowohl die „alte“ wie auch die „neue“ Generation der unique unseren Lesern viel Vergnügen bei der Lektüre dieser Ausgabe.
Ausgabe 76:

Mehrere Hunderttausend Menschen sind letztes Jahr auf der Flucht vor Krieg und Gewalt nach Deutschland gekommen – in eines der wohlhabendsten Länder der Welt. Ein Land, das 70 Jahre zuvor, von dem Krieg, das es über Europa gebracht hatte, nun selbst zerstört, in wenigen Jahren zwölf Millionen Menschen auf der Flucht aufgenommen hatte. Trotz Vorurteilen und Anfeindungen haben sich diese Flüchtlinge in den deutschen Alltag eingefügt, ihre Interessensverbände prägten in den 1990er Jahren gar die gesamtdeutschen Erinnerungsdebatten. Wie sich Deutsche mit „Vertreibungshintergrund“ nun zur aktuellen „Flüchtlingskrise“ positionieren, lest ihr in einem Gastbeitrag auf Seite 13.
Die deutsche Sprache ist für Geflüchtete einer der Schlüssel dafür, sich in Deutschland einzuleben. Ihre Vermittlung wird mehr und mehr von ehrenamtlichen Helfern übernommen. Wie das Thüringer Sprachnetzwerk für sie Weiterbildungen organisiert, damit die Qualität der ersten Sprachvermittlung für Neuangekommene gesichert ist, erfahrt ihr in unserem Artikel auf Seite 26.
Chancen auf Bildung und eine Zukunftsperspektive erhofften sich auch viele junge Menschen, die ab Ende der 1970er Jahre aus Mosambik nach Deutschland kamen. Gemäß offiziellen Verträgen zwischen der DDR und der südostafrikanischen Volksrepublik sollten sie in den ostdeutschen Betrieben ausgebildet werden, um danach als Wissenselite in ihre Heimat zurückzukehren. Tatsächlich wurden die Mosambikaner nur als billige Hilfsarbeitskräfte eingesetzt, waren Anfeindungen ausgesetzt und kehrten spätestens nach der Wende in ein vom Bürgerkrieg zerstörten Land zurück, das ihnen fremd geworden war und sie alles andere als willkommen hieß. Birgit Weyhe erzählt in ihrer Graphic Novel, die wir auf Seite 22 vorstellen, eindrücklich von dieser Erfahrung der doppelten Entwurzelung.
In einer besseren Situation als die mosambikanischen Vertragsarbeiter befindet sich der Ukrainer Kirill: Der 21-jährige aus Kiew studiert Wirtschaftswissenschaften an der Martin-Luther-Universität in Halle. In einem Gastbeitrag der hallischen Studierendenzeitschrift hastuzeit (S. 12) erzählt der Ukrainer, dass er sich in der Saale- wie auch in der Dnepr-Stadt heimisch fühlt – nach seinem Abschluss kann er sich vorstellen, in der einen oder der anderen einen Job anzunehmen. In Thüringen könnte ihm dabei unter Umständen STAY behilflich sein, ein Netzwerk, das dabei hilft, internationale Uni-Absolventen an hiesige Unternehmen zu vermitteln (S. 9).
Ali Koohzadi hingegen hat sich noch nirgendwo richtig eingefügt. Der Iraner, den wir auf Seite 6 portraitieren, begeisterte sich früh für Taoismus und ostasiatische Kampfkunst, floh vor Repressionen in seiner Heimat, studierte Wushu in chinesischen Klöstern und landete schließlich mit unsicherem Aufenthaltsstatus in Georgien. Der Perser sucht immer noch – nach seinem inneren Selbst. Ihr hingegen werdet in unserer neuen Ausgabe im Semester hoffentlich interessante Menschen, Themen und Geschichten finden.
Ausgabe 75:

Zueinanderfinden – das ist gleichermaßen Motivation und Grundstein des Dialogs: Dem Miteinander geht immer ein Zueinander voraus. Im interkulturellen Bereich, dem wir uns bei der unique seit jeher verschrieben haben, gilt das natürlich umso mehr. Es ist also nur folgerichtig, dass sich diese Ausgabe, die gleichzeitig das 15-jährige Bestehen unseres Magazins markiert, dem Zueinander widmet. Wir haben Menschen getroffen, die nicht nur geografisch von nah und fern stammen – einige scheinen, obwohl sie in Deutschland ihre Heimat haben, in einer für uns völlig fremden Welt zu leben.
Seine Exzellenz der französische Botschafter in Deutschland mag in dieser Ausgabe unser prominentester Experte für das Zueinander sein. Unsere Begegnung mit Philippe Étienne könnt ihr in Interviewform auf Seite 14 finden, wo er über seine persönlichen Erlebnisse im wiedervereinigten Deutschland und die Zukunft des deutsch-französischen sowie des europäischen Miteinanders spricht.
Europäischen Diktaturen widmet sich diesmal unser memorique ab Seite 12 – genauer gesagt: deren Aufarbeitung und der Entschädigung ihrer Opfer. Es zeigt sich dabei, dass das Zueinander eben nicht automatisch nach dem Motto „die Zeit heilt alle Wunden“ von allein geschieht – und dass in vielen Ländern Europas noch einige Anstregung zur Aussöhnung nötig sein wird.
Von einem anderen Kontinent kam der Streetart-Künstler DeStreet zu uns nach Jena. Im Porträt über ihn könnt ihr ab Seite 17 mehr über seinen Werdegang, sein Schaffen und die Menschen erfahren, die mit seiner Hilfe eine neue Perspektive in Uganda fanden. Ab Seite 9 erhaltet ihr hingegen Einblicke in das Leben eines Menschen, der zwar nicht von weit weg stammt, aber trotzdem sehr weit von der Lebenswelt der meisten Leser entfernt arbeitet: „Sklavin Tara“ berichtet aus ihrem Beruf als Sexworkerin im SM-Bereich.
In einem romantischeren Sinn zueinander fanden unsere aus Ungarn stammende Redakteurin und ihr deutscher Ehemann. Was sie ab Seite 6 beschreibt ist allerdings keine klassische Lovestory, sondern ein pointierter Bericht darüber, wie die deutsche Bürokratie versucht, ihrer Ehe mit einem deutschen Mann allerlei Steine in den Weg zu legen. Ihr Kampf gegen antiquierte Regelungen und nicht weniger antiquierte Einstellungen einiger Beamter erinnert dabei an den berüchtigten Kampf gegen Windmühlen – die hier allerdings durch latenten Rassismus auffallen.
Für diejenigen, die sich auch abseits des Zueinanders interessieren und informieren möchten, bieten wir darüber hinaus auf Seite 23 albanische Poesie, die besonders durch Kodifizierung der Regionalgeschichte und Heimatliebe auffällt, Gedanken zur „Immer-Mehr-Gesellschaft“ (Seite 16) und ein Interview mit dem niederländischen Comic-Zeichner Erik Kriek, der sich amerikanischen „Murder Ballads“ verschrieben hat (Seite 20). All das zusammen ergibt die 75. Ausgabe der unique, mit der wir unseren 15. Geburtstag feiern. Wir wünschen viel Spaß beim Lesen, Stöbern und Entdecken.
Ausgabe 74:

Deutschland 2016: Ein Land in Angst. Was Ende 2014 noch als „Sorgen“ bezeichnet wurde, hat sich seit der so genannten „Flüchtlingskrise“ im letzten Sommer zur Angst entwickelt: Einer Allensbach-Umfrage vom Anfang dieses Jahres zufolge befürchten fast 80 Prozent der Deutschen, dass mit der Zahl der Flüchtlinge auch die Kriminalitätsrate steigen wird. Eine Befürchtung, die eine paradoxe Entsprechung in der Realität findet: Im Vergleich zum Vorjahr hat sich 2015 die Zahl der Angriffe auf Flüchtlingsunterkünfte verfünffacht. Ein geständiger Tatverdächtiger, der im sauerländischen Altena ein Flüchtlingsheim angezündet hat, gab „Angst“ als Tatmotiv an.
In einem Land, in dem ängstliche Menschen andere verbrennen wollen, stellt sich die Frage, wer eigentlich hier vor wem Angst haben muss? Die afrodeutsche Moderatorin und Filmemacherin Mo Asumang fürchtet sich tatsächlich vor brennenden Flüchtlingsunterkünften – ihre ganz persönlichen Ängste im Umgang mit gewalttätigen Rassisten, Neo-Nazis und mittlerweile auch Personen wie Postmitarbeiterinnen hat die Autorin von Mo und die Arier mittlerweile durch ihre investigativen Recherchen überwunden. Darüber und über die politische Instrumentalisierung von Ängsten der Deutschen spricht sie mit uns im Interview ab Seite 8. Dabei ist deutsche „Angst“ nichts Neues. Der Jurist und Philosoph Anton Wilhelm Amo sorgte bereits im 18. Jahrhundert in Mitteldeutschland für Unbehagen: Er war der erste europäische Akademiker afrikanischer Herkunft und versetzte durch seine schiere Existenz all jene in Angst, die ihre eigene Vormachtstellung als Weiße gefährdet sahen. Über den ehemaligen „Kammermohr“, der eine universitäre Laufbahn in Halle, Wittenberg und Jena absolvierte und später aufgrund massiver Anfeindungen in sein Geburtsland Ghana floh, lest ihr auf Seite 17 in einem Gastbeitrag der hallischen Studierendenschaftszeitschrift hastuzeit.
Deutsche Ängste, ängstliche Deutsche, aber auch die Angst vor Deutschen wurden nicht nur in hiesigen, sondern auch in internationalen Kinoproduktionen künstlerisch verarbeitet – und besonders oben gestellte Frage, wer eigentlich vor wem Angst haben sollte, führte immer wieder zu faszinierenden Antwortversuchen voller Ambivalenzen. Über angsterfüllte Serienmörder und zuckersüße Ex-Nazis lest ihr in unserer Zusammenstellung von zehn Filmen ab Seite 24.
Zum eigentlichen Kern von Angst dringt insbesondere der Horrorfilm vor – ein Genre, das man nicht unbedingt mit dem türkischen Kino in Verbindung bringt. Filmemacher Can Evrenol, Regisseur des Films Baskin, spricht mit uns ab Seite 22 über realistische Alpträume und langsam zerbrechende Männlichkeitsbilder in der Türkei.
Definitiv zerbrochen ist mit den Reaktorunfällen in Tschernobyl und Fukushima die Vorstellung von der Beherrschbarkeit der Atomenergie. Was folgte war die politische Institutionalisierung des GAUs und eines Lebensalltags mit dem „Restrisiko“, argumentiert unser Beitrag zum Doppeljahrestag ab Seite 14. Mit dieser verbliebenen Angst haben sich die meisten Staaten arrangiert, Deutschland hat sie mit dem Atomausstieg ausgeräumt – zumindest in dieser Sache.
Ausgabe 73:

Die Chancen und Herausforderungen, die interkulturelles Zusammenleben mit sich bringen, gehören seit jeher zu den Kernthemen der unique – und stehen seit Sommer 2015 wie noch nie im Mittelpunkt der öffentlichen Debatten in Europa. Die Gesellschaft für deutsche Sprache erklärte den Begriff „Flüchtling“ zum Wort des Jahres 2015. Da ein Ende der Konflikte in Somalia, Afghanistan, Irak und erst recht in Syrien nicht in Sicht ist, wird die Frage, wie sich die Bekanntschaft mit den Menschen hinter diesem Begriff gestalten kann und soll, Europa noch lange beschäftigen. Ein Jenaer Projekt, an dem Schüler des Staatlichen Berufsbildenden Schulzentrums Jena-Göschwitz und junge Flüchtlinge teilnehmen, hat für die Gestaltung dieser Bekanntschaft einen möglichen Rahmen gefunden: das Theater. Wie junge Menschen über Sprachbarrieren hinweg auf der Bühne zusammenfinden, lest ihr in unserem Beitrag auf Seite 25.
Auch in der Thüringer Landeshauptstadt stellte sich die Frage nach dem Zusammenleben von Einheimischen und Flüchtlingen – etwa auf dem Campus der Universität Erfurt. Eindrücke vom studentischen Engagement, vom Leben in der Unisporthalle als provisorischer Unterkunft und von verbindenden Fußballspielen erhaltet ihr auf den Seiten 8 bis 9.
Hanna L. ging in der Unterstützung von Flüchtlingen noch eine Stufe weiter – und wurde dafür verhaftet und verurteilt. Wie altruistisch praktizierte Flüchtlingshilfe in eine Odyssee durch deutsche Gerichte münden kann, erfahrt ihr in unserer Rezension zu Stefan Buchens Die neuen Staatsfeinde (Seite 15). Was für den aus Syrien stammenden Hanna L. selbstverständlich war, ist für andere Menschen aus Ländern mit Fluchtgeschichte undenkbar: Etwa 500.000 Ungarn flohen 1956 nach der gescheiterten Revolution aus ihrem Land – das 60 Jahre später eine der drakonischsten und repressivsten Migrationspolitiken in der EU fährt. Über die Zusammenhänge und Ursachen dieses Paradoxons lest ihr in unserem Artikel ab Seite 6. „Müllberge“ würden syrische Flüchtlinge nach Europa bringen, so ungarische „56er“-Verbände in offiziellen Stellungnahmen. Sadiq al-Azm brachte auf seiner Flucht 2012 jedoch eine lange Publikationsliste, unmittelbare Erfahrungen mit arabischen Diktaturen und einen Ruf als unermüdlicher Vorkämpfer für Säkularisierung im Nahen Osten mit. Wir haben mit dem syrischen Intellektuellen und Preisträger der Goethe-Medaille 2015 über die Perspektiven der Aufklärungsideale und das Scheitern politischer Reformprozesse in der arabischen Welt gesprochen (Seite 16 bis 17).
Erfurter Studenten und ungarische Ex-Flüchtlinge, Jenaer Schüler und syrische Intellektuelle, aber auch todesmutige Filmkünstler im Bewegungsrausch, Pelikane mit christlichem Bedeutungshintergrund sowie Comiczeichner ohne nennenswerte Erfahrungen mit Hasskommentaren – wie flüchtig eure Begegnungen in unserer neuen Ausgabe auch sein mögen: Wir wünschen euch eine erkenntnisreiche und interessante Lektüre.
Ausgabe 72:

Seit dem Erscheinen unserer letzten Ausgabe zum Ende des Sommersemesters hat sich Vieles verändert: in Deutschland, in Thüringen, auch in Jena. Statt Sommerloch gab es eine öffentliche Debatte, die aufgeheizt war wie seit Jahren nicht mehr – landesweite und internationale Medien berichteten über brennende Asylunterkünfte, „Flüchtlingswellen“ und neue Zäune in Europa, aber auch über Willkommensgrüße, Spenden- und Hilfsbereitschaft. In der neuen Ausgabe der unique dies alles nachzuerzählen wäre wenig ergiebig, doch natürlich befassen wir uns als interkulturelles Magazin mit diesem Thema – jetzt und auch zukünftig. Und da in den öffentlichen Debatten zwar wie kaum zuvor über geflüchtete Menschen, aber noch immer viel zu selten mit ihnen gesprochen wird, haben wir letzteres getan: Über die Erfahrungen einer yesidischen Familie, die vor den Kämpfern des „Islamischen Staates“ aus ihrer Heimat fliehen musste, lest ihr ab Seite 12.
Seit Monaten dominieren also hitzige Debatten in Europa und menschliche Tragödien im Mittelmeer und Nahen Osten das öffentliche Interesse. Dabei geraten andere Teile der Welt aus dem Blick. Darum nehmen wir in diesem Heft das seit kurzem an der Universität Jena angesiedelte Thematische Netzwerk zum „Transnationalen Wandel am Beispiel Patagoniens“ zum Anlass, unsere Aufmerksamkeit auf ausgewählte Länder Lateinamerikas zu richten: Welche gesellschaftlichen Debatten gibt es; was bewegt Menschen dort; was treibt sie auf die Straße? Wir sprachen mit jungen Venezolanern, die trotz drohender Strafen gegen die Regierung ihres Landes demonstieren, weil sie sich eine andere Zukunft wünschen (Seite 10). In Argentinien dagegen engagieren sich Vertreter der älteren Generation: die „Großmütter des Plaza de Mayo“ traten und treten für die Aufarbeitung der Massenverbrechen ein, die von Militärs in den Jahren 1976 bis 1981 begangen wurden (Seite 19).
Ein Zeichen gegen die Umgestaltung des urbanen Raumes wollen viele Menschen in Santiago de Chile und Buenos Aires setzen: Mit der Geografin Corinna Hölzl sprachen wir über Gentrifizierung und Gated Communites in den Hauptstädten Chiles und Argentiniens (Seite 17).
Weitab von den Metropolen ist das Werk der patagonischen Dichterin Graciela Cros angesiedelt, die der spanischsprachige Gastbeitrag auf Seite 28 portraitiert – passend zu ihrem Besuch in Jena Anfang November, bei dem sie in einer öffentlichen Lesung über die Situation patagonischer Autoren und über die Schwierigkeiten des Schreibens aus der ‚Peripherie’ sprechen wird.
Am Rande der Gesellschaft finden sich bis heute die indigenen Quechua, deren Sprache 1938 durch den Schriftsteller und Übersetzer José María Arguedas erstmals einem breiten Publikum zugänglich gemacht wurde. Das fremde Gedicht dieser Ausgabe auf Seite 26 beschreibt eindrucksvoll die Sehnsucht der Quechua nach Heimat in der Fremde: „…wie weinen die Augen, wenn man in einer anderen Stadt ist“. Und mindestens das ist ein Gedanke, den es sich auch für die aktuelle Situation im Nahen Osten, in Deutschland und in Europa zu behalten lohnt.
Ausgabe 71:

Reisen ohne Grenzen: Diese Vision wurde vor dreißig Jahren durch das Schengener Abkommen zur Realität. Seitdem können sich die Bürger frei durch Europa bewegen. Davon profitiert auch der polnische Abenteurer Tomek. Bis heute überschreitet er immer wieder Grenzen, seien es geografische oder persönliche. Er besuchte bereits über siebzig Länder, doch es treibt ihn immer weiter. Mehr aus dem Leben des Weltenbummlers lest ihr ab Seite 6.
Doch nicht jeden treibt es freiwillig durch die Welt. Flüchtlinge begeben sich auf gefährliche Wege in der Hoffnung auf ein besseres Leben. Tarek aus dem Kosovo erzählt uns auf Seite 12 von seinen Ängsten und Träumen, und seiner Odyssee nach Deutschland. Der Kosovo, dem Tarek entfloh, war vor drei Jahrzehnten noch ein Teil Jugoslawiens. Als dessen Teilrepubliken nach neuen nationalen Identitäten suchten, zerfiel der Vielvölkerstaat. Einem ganz individuellen Weg in diesen Zusammenbruch geht die Künstlerin Nina Bunjevac nach, indem sie die Biografie ihres Vaters auf einer transnationalen Schnitzeljagd zwischen Kanada und Jugoslawien rekonstruiert. Wie ihr das gelingt, lest ihr in unserer Besprechung ihrer Graphic Novel Vaterland ab Seite 20.
Der Versuch, an der Trennung eines Landes nicht zu zerbrechen, kennzeichnet auch das literarische Werk des koreanischen Dichters Ko Un. Geprägt durch den Krieg und die darauf folgende Teilung Koreas ist seine Lyrik eine Verarbeitung der traumatischen Spaltung seiner Heimat. Über ihn und aus seinem Werk lest ihr mehr ab Seite 24. Kaum überwindbare Grenzen existieren jedoch nicht nur geografisch, sondern auch im Kopf. Kunst hat diese schon immer überwunden oder neu definiert. Die Romane Lady Chatterley und Wendekreis des Krebses sorgten bei ihrer Publikation für einen Eklat und verwischten dabei die Grenzen zwischen Pornografie und Kunst. Über Sex in der Literatur, gesellschaftliche Moralvorstellungen und eine kleine Revolution in der Zensurgeschichte lest ihr ab Seite 28.
Um Zensur muss sich der Künstler Konrad Henker zwar nicht sorgen, dafür jedoch um sein körperliches Wohlbefinden: Jedes Jahr sucht er Inspiration für seine Kaltnadelradierungen in den Tiroler Alpen und gerät dabei an physische Grenzen. Mehr über ihn und seine Werke erfahrt ihr auf Seite 8.
Auch in unserer eigenen Redaktion überschreiten wir die Grenzen – der Zeit. Schon seit April 2010 schreibt Professor Thomas Honegger vom Institut für Anglistik der Uni Jena für uns regelmäßig seine Sprachkolumne – und natürlich auch für diese 71. unique auf Seite 27. An dieser Stelle ein besonders herzliches Dankeschön.
Ausgabe 70:

Samson wurde von Delila verraten, Achilles weigerte sich zu kämpfen, da man ihm die schöne Briseis vorenthielt, Nephthysis wurde zum Spielball zwischen Osiris und Seth. Doch nicht nur in der Mythologie führte das Verlangen nach einer Frau zu Aufstieg und Niedergang der Starken und Mächtigen. Jahrhunderte lang hüteten Mätressen nicht nur das Bett von Königen und Fürsten, sondern hatten auch großen Einfluss auf die Geschicke ganzer Nationen. Mehr dazu lest ihr auf Seite 11.
Verführung ist aber mehr als nur Leidenschaft und Sinnlichkeit; sie ist Zauber. Seit jeher ziehen Magier das Publikum in ihren Bann. Durch raffinierte Tricks und aufwendige Techniken zerstückeln sie etwa Jungfrauen oder lassen die Freiheitsstatue verschwinden. Zwei Könner des Fachs erzählen uns ab Seite 5 von ihrem Werdegang sowie von den Hürden und Gefahren der Berufsmagie. Auch der Filmemacher Orson Welles war Zeit seines Lebens ein leidenschaftlicher Magier. Der Schöpfer von Meisterwerken wie Citizen Kane oder Touch of Evil war getrieben von dem Wunsch nach Neuem. Trotz Widerstand der großen Studios in Hollywood und des Scheiterns seiner Filme an US-amerikanischen Kinokassen ging Welles seinen Weg und revolutionierte das Kino. Anlässlich seines 100. Geburtstags ehren wir ihn ab Seite 18 mit einem Portrait.
Wer verführt wird, kann sich auch verlieren. Egal ob Disneyland, die Arktis oder der Mars: Alles ist nur einen Mausklick entfernt – ermöglicht durch digitale Parallelwelten. Die Spieleindustrie macht damit jährlich Millionenumsätze. In den letzten Jahren entwickelten sich neue Wirtschaftszweige fernab vom klassischen Gamedesign: Let’s Player bannen mit ihren Spielmitschnitten tagtäglich tausende Zuschauer auf YouTube und ihre Abonnentenzahlen schießen in die Höhe. Über diese besondere Entwicklung in der Welt der Games, ihre Faszination und ihre Wirkungen lest ihr auf Seite 17. Auch wir hoffen, dass wir euch mit unserer 70. Ausgabe etwas verführen können und wünschen euch eine fesselnde Lektüre und einen guten Start ins neue Semester.
Ausgabe 69:

Wer spricht denn heute noch von der Vernichtung der Armenier?“, fragte Adolf Hitler rhetorisch 1939 am Vorabend des Zweiten Weltkriegs. Als Aghet, ‚die große Katastrophe‘, bezeichnen die Betroffenen die Ereignisse ab dem 24. April 1915. In den folgenden Jahren fielen im Osmanischen Reich Schätzungen zufolge bis zu 1,5 Millionen Armenier der Vernichtung zum Opfer. Doch ein Völkermord hat hier nie stattgefunden – zumindest nach dem offiziellen türkischen Narrativ: Der Krieg habe die Deportationen in die Wüste gefordert; die zahlreichen Toten seien auf „unglückliche Umstände“ und vereinzelte Übergriffe zurückzuführen. Viele Berichte von ausländischen Diplomaten, Ärzten und Missionaren belegen jedoch das Gegenteil.
Dem systematischen Massenmord gingen Zeiten der Spannung voraus. Schon lange siechte der „kranke Mann am Bosporus“, Konflikte im Grenzgebiet zu Russland standen auf der Tagesordnung. Inmitten dieser Unruhen wurde der vermeintliche Grund für die Schwächung des Osmanischen Reichs gefunden: Die angebliche Allianz von Armeniern in Ostanatolien und den Russen – die armenische Dolchstoßlegende war geboren.
Am 24. April 1915 veranlassten die seit 1908 regierenden Jungtürken die Verhaftung der armenischen Eliten. Dieser Tag markiert heute den Beginn des Völkermordes. In den Folgejahren wurde ein Großteil der armenischen Bevölkerung in die Wüste deportiert. Augenzeugen berichten von Plünderungen, Vergewaltigungen und tausenden von Leichen, die die Deportationswege säumten. Die Todesmärsche wurden von sogenannten „Gendarmen“ bewacht, Corps gebildet aus anderen Minderheiten. Mit deren Motiven für die Mitwirkung am Völkermord beschäftigen uns ab Seite 21. Die Gefangenen, die ihren Zielort erreichten, starben meist an Hunger und Krankheiten, andere wurden erschossen. Von dem grausamen Geschehen zeugen zeitgenössische Fotografien; einige davon sind in unserem Foto-essay auf Seite 12 zu sehen. Doch obwohl durch Meldungen ausländischer Beobachter auch andere Staaten über die dramatischen Ereignisse im Osmanischen Reich im Bilde waren, drang selten Hilfe zu den Verfolgten vor. Ihr standen nicht nur der Widerstand der osmanischen Regierung, sondern teils auch wirtschaftliche und politische Interessen im Weg. Welche Rolle die Bagdadbahn, ein infrastrukturelles Mammutprojekt des Deutschen Reiches, im Genozid spielte, lest ihr ab Seite 19.
Das Verbrechen gegen die Menschlichkeit hat die Heimat der Armenier für immer verändert. Vor Aghet lebten ungefähr zwei Millionen Armenier im Imperium am Bosporus, hauptsächlich in Ostanatolien – in der heutigen Türkei sind es nur noch 60.000. Der Rest lebt in Armenien und in der Diaspora; vor allem in Westeuropa und den USA. In der armenischen Kultur ist die Heimatlosigkeit daher auch ein omnipräsentes Thema. Wie sie literarisch verarbeitet wird, illustriert ein armenisches Gedicht auf Seite 31.
Adolf Hitlers berühmtem Zitat zum Trotz wurden die Armenier nicht von allen vergessen. Der Prager Schriftsteller Franz Werfel etwa verfasste ein Heldenepos über die Leiden der Armenier: Über Die vierzig Tage des Musa Dagh lest ihr in unserer klassiquer-Rubrik ab Seite 32. Auch andere Künstler – ob armenischstämmig oder nicht – befassten sich in ihren Büchern, Filmen, Dramen und Gemälden mit dem armenischen Völkermord, wovon wir ab Seite 28 berichten.
Die unaufgearbeitete Katastrophe und die Leugnungspolitik des türkischen Staates stellten unsere Redaktion zunächst vor eine kaum zu bewältigende Aufgabe: Wie können wir euch Aspekte eines Geschehens präsentieren, das gemäß den Regierenden im Täternarrativ nicht stattgefunden hat? Die Anerkennung, gar die Nennung des Genozids als solchen, steht in der Türkei noch immer unter Strafe. Wohl auch deswegen erhielten wir kaum Rückmeldungen von türkischen Stellen oder Befragten in der Türkei. Trotzdem erklärten sich einige ausgewiesene Experten dazu bereit, mit uns zu sprechen, wie der Publizist Wolfgang Gust, der umfangreiche Dokumente zum armenischen Völkermord aus den Archiven des Auswärtigen Amts ausgewertet und herausgegeben hat.
2015 ist ein „großes“ Gedenkjahr: 70 Jahre Ende des Zweiten Weltkrieges, 25 Jahre Deutsche Einheit. Mit dieser Ausgabe möchten wir auf ein nicht minder wichtiges Ereignis der neueren Geschichte hinweisen – und uns den Leugnungsbestrebungen und dem Vergessen entgegensetzen.
Ausgabe 69 wurde finanziell unterstützt durch
![]()
Ausgabe 68:

„Diese Nacht erfüllten Gestalten der Angst/ Die leeren Flure dicht/ Und auf und ab die Eisenstadt/ Schlichen Füße, – wir hörten sie nicht/ Durchs Stangenviereck, das die Sterne versteckt/ Spähte ein weißes Gesicht“ – in rund 109 Strophen beschreibt Oscar Wilde den Alltag in staatlichen Besserungsanstalten in der Ballade vom Zuchthaus zu Reading. Der Schriftsteller wurde im Jahre 1895 wegen seiner Homosexualität zu Zwangsarbeit verurteilt. Der Ire war nicht der einzige Autor, der Gefängnismauern von innen sah: Hans Fallada saß wegen eines fehlgegangenen „Doppelsuizids“ für Totschlag ein. Auch Fjodor Dostojewski wurde auf Grund von regierungskritischen Aktivitäten in ein Arbeitslager in Sibirien deportiert. Beide verarbeiteten diese Erfahrungen literarisch. Mehr dazu lest ihr in unserem klassiquer ab Seite 33.
Auf engstem Raum eingesperrte, weitgehend entrechtete Menschen und sich daraus ergebende Macht- und Gesellschaftsstrukturen sind auch für andere Medien ein dankbarer Ausgangspunkt. So beschäftigen sich unter anderem zahlreiche Filme mit dem Leben hinter Gittern. Eine Auswahl findet ihr ab Seite 25.
So grausam die Schilderungen in Buch und Film auch sein mögen, sie lassen doch immer den Notausgang der Fiktion. Anders verhält es sich bei realen Haftbedingungen in Gefängnissen: Eine ausführliche Einführung in die Probleme französischer Haftanstalten bietet ein Gastartikel ab Seite 22. Doch eine Justizvollzugsanstalt soll Häftlingen auch die Möglichkeit geben, wieder ein Teil der Gesellschaft zu werden. Diese Resozialisierung wird unter anderem von Sozialarbeitern oder Geistlichen begleitet. Sie gewähren uns einen Einblick in ihren ungewöhnlichen Berufsalltag (ab Seite 6 bzw. Seite 13).
Vom Freiheitsentzug selbst ist nur ein Bruchteil der Bevölkerung betroffen – überdurchschnittlich häufig jedoch ausländische Mitmenschen. Über mögliche Ursachen dieser Überrepräsentation lest ihr in unserem Interview mit einem Strafvollzugsexperten ab Seite 18.
„Illegaler Aufenthalt“ ist einer jener Straftaten, die nur Ausländer begehen können. Der Status als „Illegaler“ hat jedoch nicht nur auf rechtlicher Ebene Einfluss: Von der künstlerischen Verarbeitung eines Schicksals in der Schattenwelt lest ihr ab Seite 27. Nicht jede Migration endet jedoch im Elend. Wie sehr ein funktionierendes Netzwerk eine Integration beschleunigen kann, erfahrt ihr anhand der Geschichte eines syrischen Mediziners ab Seite 8.
Auch wenn einige der Artikel doch schwer im Magen liegen mögen, wünschen wir euch nun einen guten Start in das neue Semester und eine informative Lektüre.
Ausgabe 67:

„Mein lieber Lord Boyet, obwohl meine Schönheit nur durchschnittlich ist / benötigt sie nicht die Ausschmückung eures Lobgesangs, / denn Schönheit liegt im Auge des Betrachters / und muss nicht durch die Zunge des Hausierers angepriesen werden.“ – sprach die Prinzessin von Frankreich in William Shakespeares Komödie Verlorene Liebesmüh. Heute, 450 Jahre nach seiner Geburt (mehr zu ihm auf Seite 33), liegt Schönheit zwar immer noch im Auge des Betrachters, kann jedoch wesentlich einfacher, dank Skalpell, „ausgeschmückt“ werden. Die Plastische Chirurgie, die im späten 19. Jahrhundert für zunehmend selbst- und körperbewusste bürgerliche Schichten als Instrument der Schönheitsoptimierung weiter entwickelt wurde, hat eine Jahrtausende alte Geschichte. Darüber und über ihre primäre Funktion – der Beseitigung schwerer Verstümmelungen – lest ihr in unserem Titelartikel auf Seite 12.
Eine ebenso wechselvolle Geschichte im Bereich der Körpermodifikation zeigt sich bei Tattoos: Im westlichen Kulturkreis galten sie bis vor Jahrzehnten als Attribut von Kriminellen, Prostituierten und anderen gesellschaftlichen Randgruppen und besonders als stigmatisierendes Zeichen einer Gefängniskultur. Doch was passiert heute, da Tattoos ‚Mainstream‘ geworden sind, mit ehemaligen Häftlingen, für die die „Geschichten auf der Haut“ eine Auflehnung gegen die Institution Gefängnis darstellten? Auf Seite 26 gehen wir dieser Frage nach.
Ganz ohne permanente Eingriffe in die Physis kommt die Freikörperkultur aus, die als ‚typischer‘ Bestandteil des DDR-Alltags gilt. In den 1950er Jahren existierte jedoch eine Bewegung, die nackte Haut mit karnevalesken Kostümfesten, exotischem Eskapismus und einer Proto-Hippie-Attitüde verband: die sogenannten Kamerunfeste. Diese waren dem Regime ein Dorn im Auge – Innenminister Karl Maron sprach im damaligen Duktus von einer „Schmähung der Sitten und Gebräuche der Negervölker“. Ein Bild von diesen Veranstaltungen könnt ihr euch mit unserem Fotoessay auf Seite 10 machen.
Das Ende des Kommunismus führte in Ostdeutschland zu keinem Revival der Kamerunfeste, in Albanien jedoch zu einem Wiederaufleben traditioneller Blutfehden – und damit auch einer Praxis, die wahrgenommene Unterschiede zwischen den Geschlechtern aufhebt: Über die „Eingeschworenen Jungfrauen“, die als Frauen geboren werden, nach einem Schwur aber als Männer leben, lest ihr ab Seite 16.
Bei der Lektüre unserer körperbetonten 67. Ausgabe wünschen wir euch viel Vergnügen. Ein Special zu den Internationalen Tagen, die bis zum 24. Mai in Jena stattfinden, findet ihr ab Seite 18.
Ausgabe 66:

Bei der Trauerfeier für den verstorbenen Nelson Mandela im letzten Dezember sorgte Thamsanqa Jantjie für Verwunderung und Unmut: Der offizielle Gebärdendolmetscher der Veranstaltung gestikulierte stundenlang völlig unverständlich. Breit diskutiert wurde seine kriminelle Vergangenheit – in dem Trubel gingen dabei die empörten Äußerungen internationaler Gehörlosenverbände unter. Denn die Gebärdensprache ist keineswegs „nur“ ein Hilfsmittel, sondern eine eigene Sprache, die seit 2006 von der UNO als solche auch anerkannt wird – zumindest auf dem Papier. Dennoch sehen Vertreter der sogenannten Deafhood -Bewegung ihre Sprache nicht nur von einer Dominanz der hörenden Kultur bedroht, sondern auch vom Cochlea-Implantat, das Gehörlose wieder (teilweise) hören lässt und die Gebärdensprache „obsolet“ werden ließe: Eine Debatte, die auch heikle medizinethische Fragen aufwirft, und die wir in unserem Leitartikel auf Seite 15 zum Thema machen. Die Gebärdensprachdolmetscherin Jana Hayn spricht im Interview mit uns über ihre praktischen Erfahrungen mit der Gebärdensprache im höheren Bildungswesen (Seite 17).
Auch der griechische Schriftsteller Petros Markaris ist ein Dolmetscher zwischen zwei Sprachen: Er verfasst nicht nur erfolgreiche Kriminalromane, sondern hat auch Goethe und Brecht ins Griechische übertragen. Im Interview auf Seite 30 spricht der gebürtige Istanbuler und Preisträger der Goethe-Medaille 2013 über seine besondere Beziehung zu Goethes Faust – einen Ausschnitt aus seiner Übersetzung findet ihr in unserer Rubrik zum fremden Gedicht (Seite 28).
In Lettland, dem nunmehr 18. europäischen Staat, in dem der „Eiro“ eingeführt wurde (Seite 6), tobt hingegen seit der Unabhängigkeit 1991 eine heftige Geschichtskontroverse um die Rolle lettischer Soldaten während des Zweiten Weltkriegs. Ab Seite 18 werden ihre Grundzüge dargestellt: Geführt wird die Debatte von Gruppen, die einander nicht zuhören wollen.
Genau dieses Zuhören ist die zentrale Aufgabe, die eine Telefonseelsorge zu erfüllen hat. Die in Berlin ansässige MuTeS (Muslimische TelefonSeelsorge) hat seit 2009 ein offenes Ohr für die Menschen, die sich mit ihren Alltagsproblemen an sie wenden. Sie ist zwar weniger bekannt als dieselben Organisationen christlicher Prägung, erreicht aber mittlerweile Hilfebedürftige auch über die Glaubensgrenzen hinweg (Seite 5).
Die 66. Ausgabe der unique lädt natürlich auch im neuen Jahr nicht unbedingt zum Hören, sondern primär zum Lesen ein. Unseren Lesern, die bei unserer Umfrage mit ihren Anmerkungen, ihrer Kritik und ihren Vorschlägen einen neuen Input für 2014 gegeben haben, gilt ein besonderer Dank. Den Gewinner der Verlosung findet ihr in übrique auf Seite 34.
Ausgabe 65:

„Wer Einwände gegen diese Verbindung vorzubringen hat, der möge jetzt sprechen – oder für immer schweigen.“ Diesen oder ähnliche Sätze kennt wohl jeder, heiratswillig oder nicht, mindestens von filmischen Trauungen. Üblicherweise verpuffen sie im rhetorischen Nirvana – nicht jedoch, wenn das künftige Ehepaar gleichgeschlechtlich ist. Dann werden oftmals lautstarke Einwände vorgebracht: Nicht nur Individuen, sondern teils große und gut organisierte gesellschaftliche Gruppierungen, ob nun religiös oder (partei-)politisch, stemmen sich bis heute gegen die völlige rechtliche Gleichstellung homosexueller Paare. Wer sind diese Gegner, die nicht „für immer schweigen“ mögen? Wie argumentieren sie? Und wohin bewegen sich insgesamt westliche Gesellschaften bezüglich der Stellung der gleichgeschlechtlichen Ehe? Diesen Fragen haben wir uns ausgiebig ab Seite 15 anhand von drei prominenten Fallbeispielen gewidmet.
Auch wenn hierzulande die völlige Gleichstellung (noch) nicht erreicht ist, sehen sich homosexuelle Paare in anderen Regionen der Welt mit noch größeren Problemen konfrontiert: In zahlreichen Ländern Asiens und Afrikas drohen ihnen schwere Strafen für ihre sexuelle Orientierung: Geldbußen, Verhaftung, teilweise sogar der Tod. Wie verschiedene afrikanische Gesellschaften – im Vergleich zu Europa, aber auch untereinander – mit homosexuellen Lebensentwürfen umgehen, lest ihr ab Seite 6.
Repressalien gegen Homosexuelle sind keine Grundkonstante der Menschheitsgeschichte, sondern kamen vielerorts (gerade auch in Afrika) durch die Verbreitung monotheistischer, christlicher und islamischer Religionen zustande, weiß der Historiker Robert Aldrich zu berichten. In unserem Titelinterview ab Seite 18 spricht der Australier auch über die Rolle der Aufklärung bei der Durchsetzung homophober Restriktionen, über den langjährigen Kampf Homosexueller für ihre Emanzipation und über die subversive Kraft der Liebe.
Unterschwellig subversiv war auch schon immer die mittlerweile als Kultklassiker geltende Zeichentrickserie Die Simpsons, mit ihren vielfältigen politisch-sozialen Subtexten. Zu diesen gehörte auch schon die Frage nach der Repräsentation von und dem Umgang mit Homosexualität. Ein kürzlich erschienenes Sachbuch beleuchtet mit großer Liebe zum Detail diesen Themenkomplex. Unsere Rezension von Hinter den schwulen Lachern findet ihr auf Seite 25. Doch bevor ihr zu diesem empfehlenswerten, gleichwohl nüchtern geschriebenen Sachbuch greift (oder den Fernseher für die nächste Episode mit den gelben Springfield-Bewohnern anschaltet), wünschen wir euch viel Spaß, aber auch viele erhellende Einblicke und Anregungen zu weiteren Gedanken bei der Lektüre unserer 65. Ausgabe.
Ausgabe 64:

Der Journalismus wird gerne als Vierte Macht im Staat bezeichnet. Über Zeitung, Radio und Fernsehen stellen Journalisten ihre Informationen und Erfahrungen einem breiten Publikum zur Verfügung. Um stets auf dem neusten Stand und ganz nah am Geschehen zu sein, müssen die Berichterstatter häufig von Ort zu Ort ziehen. Wie sich das Leben zwischen den verschiedenen Stationen der Berichterstattung anfühlt und vor allem was die Rastlosigkeit für das Heimatgefühl bedeutet, berichtet der Schweiz-Korrespondent der Süddeutschen Zeitung, Wolfgang Koydl, im Interview auf Seite 10.
Zwar ist die Unabhängigkeit der Medien eine der wichtigsten Errungenschaften eines demokratischen Staates, aber auch hier wird gespart. Diese Maßnahmen treffen vor allem Reporter, die sich an Krisenorte wagen. Da die Zahl solcher Journalisten abnimmt, müssen auch die deutschen Medien ihre Informationen immer häufiger aus YouTube-Videos oder von Blogs beziehen. Stephan Kloss unterzieht diese Entwicklung im Interview auf Seite 12 einer kritischen Betrachtung.
Wie das im Gespräch mit Profis immer so ist, tauchen eine ganze Menge Wörter auf, die nicht sofort verständlich sind. Eine Orientierungshilfe im Dschungel des Medienmenschen-Fachjargons bietet Euch unser Journalismus-ABC auf Seite 18.
Journalisten scheinen die Vorreiter der Meinungsfreiheit zu sein – diejenigen, die darüber schreiben, was schief läuft und kein Blatt vor den Mund nehmen; gerade in totalitären Staaten gelten sie daher oft als Gefahr. Aber sie sind bei Weitem nicht die Einzigen, die durch kritische Arbeit in das Visier der Regime geraten. Auch Künstler scheinen immer potentielle Revolutionsführer zu sein; um den Umbruch zu unterdrücken, werden also auch sie unter besondere Beobachtung gestellt. Unsere Budapest-Korrespondentin ermöglicht auf Seite 15 einen Einblick in die Situation junger Kreativer in Ungarn.
Gewehrt haben sich die Menschen in Iran vor vier Jahren: Die Grüne Revolution ließ die Welt für ein paar Wochen gebannt auf die vermeintliche Atommacht schauen. Doch mit dem Abebben der Proteste erlosch auch das Interesse der westlichen Medien. Anlässlich der Wahl eines neuen Präsidenten wollten wir wissen, wie es heute in Iran aussieht: Was ist übrig geblieben von der Aufbruchsstimmung von damals? Und was beschäftigt die jungen Leute in Iran heute? Einblicke in das Land gibt unser Informant auf Seite 8.
Es gibt also jede Menge Journalismus innerhalb und außerhalb der Grenzen Europas zu entdecken. In diesem Sinne wünscht Eure Vierte Macht vor Ort ein sonniges Gemüt und sonnige Tage und hofft, dass dieses vielseitige Heft Euch eine gute Lektüre bis zu und in den Semesterferien bietet.
Ausgabe 63:

Es gibt weltweit rund 6.500 verschiedene Sprachen. Bei dieser Vielfalt werden für die internationale Verständigung oft Sprachmittler gebraucht: Dolmetscher helfen schon seit ungefähr 100.000 Jahren bei der Kommunikation – fast so lange, wie die Menschheit spricht. Je globaler unser Leben wird, desto grenzüberschreitender wird auch die Politik. Damit dabei keine Missverständnisse entstehen, braucht man Menschen, die in der Lage sind, auch feine Nuancen von der einen in die andere Sprache zu übertragen. Wie die Verständigungshilfe auf der Bühne der großen Politik funktioniert, berichtet Ivan Ivanj, der Dolmetscher des ehemaligen jugoslawischen Staatspräsidenten Tito, im Interview auf Seite 8.
Ivanji ist in seinem Beruf nie in Konflikt mit seinem Gewissen geraten und stand stets hinter der Meinung, die er zu übersetzen hatte. Die Übereinstimmung von eigenen Überzeugungen und dem Gesagten ist jedoch für Dolmetscher keineswegs selbstverständlich: Wie es sich anfühlt, im bilateralen Kontakt eine Meinung aussprechen zu müssen, die der eigenen nicht entspricht, berichtet unsere Redakteurin auf Seite 10. Die Übersetzertätigkeit ist normalerweise ein Beruf, der durch eine Ausbildung erlernt wird. Doch in Deutschland gibt es viele kleine Dolmetscher, die diese Aufgabe ohne professionelle Vorbereitung erfüllen müssen. Welche Probleme das mit sich bringt, schildert unser Artikel über die „Familienaußenminister“ auf Seite 35.
Neben vielen natürlichen Sprachen existiert auch eine Reihe von Kunstsprachen. Wie sich diese unterscheiden und welche Geschichten dahinterstecken, erklärt Anglistik-Professor Thomas Honegger in seiner Kolumne auf Seite 34. Eine der bekanntesten Kunstsprachen entwickelte J.R.R. Tolkien in seiner epischen Trilogie Der Herr der Ringe: das Elbische. Die Sprache von Legolas und Galadriel hat bis heute viele treue Fans. Einer von ihnen hat ein elbisches Gedicht geschrieben, das wir euch auf Seite 33 vorstellen.
Von der schönen Welt der Kunstsprachen zurück auf den harten Boden der Realität führen euch zwei unserer Artikel zu aktuellen Geschehnissen: Ein Besuch in Nordkorea bescherte dem Studenten Roman bleibende Eindrücke und lehrte ihn nicht nur den Wert der Freiheit zu schätzen. Fotografische Zeugnisse seiner Reise in die Diktatur findet ihr auf Seite 14.
Nicht minder verstörend als die Drohungen aus Pjöngjang waren und sind die Berichte über Vergewaltigungen in Indien. Zwei unserer Redakteure berichten auf Seite 23 vom Subkontinent über die medial viel beachteten Proteste, die ihren Ursprung auf dem Campus der Universität in Delhi hatten.
Aus dem fernen, aufgewühlten Asien geht es nun zurück ins lauschige Thüringen. Hier wünschen wir euch viel Spaß mit unserer Ausgabe Nummer 63.
Ausgabe 62:

Man kennt diesen Satz aus unzähligen Pop-Songs und auch in der Werbekampagne eines Innenausstatters wäre er nicht fehl am Platz: „Home is where your heart is.” Vom Aushängeschild für Kitsch und Konsum bis zum Inbegriff der persönlichen Identität: „Heimat“ ist vielfältig einsetzbar. Das zeigt auch die Geschichte seiner politischen Inanspruchnahme: Zwischen der „Blut-und-Boden“-Ideologie im Dritten Reich und dem „Thüringer Heimatschutz“ scheint sich eine gewisse Kontinuität der Begriffsverwendung abzuzeichnen. Dem gegenüber stehen seit den 1960er-Jahren die ökologische Heimatpflege der grünen Bewegung und neue Postulate wie das Fatih Akins, der seine Hommage an Hamburg-Wilhelmsburg, Soul Kitchen, als „neuen Heimatfilm“ anpries. Der Entwicklung des Konzepts „Heimat“ und einer möglichen „neuen Heimat“ nähern wir uns ab Seite 19 an. Schließlich werden wohl wenige Begriffe so häufig und in unterschiedlichen Kontexten bemüht: Manche halten ihn für einen „ur-deutschen Mythos“ – Kulturwissenschaftler und Anthropologen dagegen sehen in ihm eine universal menschliche Kategorie. Früher dachte man womöglich an ein ländliches Idyll, wenn von „Heimat“ die Rede war. Heute fällt der Begriff auch im Kontext des Städteviertel-Umbaus. Dabei sind Kulturräume selten streng abgegrenzte Inseln. Über fließende Identitäten und den Versuch, die eigene Heimat zwischen Polen, Deutschland und Schlesien zu definieren, lest ihr ab Seite 12.
Gerade auf Reisen werden die eigenen Wurzeln oft zum Fluchtpunkt – man hat Heimweh. Was einen ursprünglich aber vom angestammten Ort forttrieb, war das Fernweh. Mit dem Widerspruch dieser beiden Gefühle setzen wir uns auf Seite 9 auseinander. Dass man zum Ort seiner Herkunft durchaus ein gespaltenes Verhältnis haben kann – vor allem, wenn man in einiger Distanz zu ihm lebt – zeigt eine Gegenüberstellung auf Seite 8.
Der Blick aus der Ferne bestimmt auch unsere Rezension eines Mangas, der Deutschland überraschend aufschlussreich porträtiert, ohne dass der japanische Autor hierfür einen biographischen Bezug zum Land geltend machen müsste (S. 36). Schritt für Schritt entfernen wir uns damit von einem exklusiven „Heimat“-Begriff, der die jeweils „Anderen“ ausschließt und eine innere Einheit behauptet, wo keine ist.
So beginnen wir das Jahr 2013 mit einem Thema, das uns herausfordert zum Umdenken, zum Neudenken des Gewohnten – was Voraussetzung ist für gegenseitiges Verständnis und Austausch zwischen Kulturen inner- und außerhalb der Hochschule. Für diesen Anspruch erhielten wir im Dezember 2012 eine Auszeichnung vom „Bündnis für Demokratie und Toleranz“ der Bundeszentrale für politische Bildung. Wir möchten uns an dieser Stelle bei allen Förderern und Unterstützern der unique bedanken, die diesen Erfolg möglich gemacht haben und wünschen viel Spaß bei der Lektüre der 62. Ausgabe.
Ausgabe 61:

Wie willkommen sind Fremde in Deutschland im Allgemeinen und in dessen „grünem Herzen“ im Speziellen wirklich? Wie kommen sie an, wo und wie wohnen sie, wie richten sie sich ihr Leben in ihrer neuen Heimat ein? Und was tun die einheimische Bevölkerung, die Behörden und die Universitäten, um die Ankunft der temporären Gäste und der permanenten Neubewohner zu erleichtern? Jena hat sich 2008 mit einem kommunalen Plan weitreichende Ziele gesetzt, um die Integration der Zugewanderten voranzutreiben. Viele der Vorgaben des Integrationskonzepts sollten bis Ende 2012 umgesetzt werden. Was davon geschafft wurde und wo noch Handlungsbedarf besteht, haben wir auf den Seiten 16 bis 19 recherchiert.
Währenddessen blockiert die deutsche Bundesregierung vehement einen Gesetzesentwurf der Europäischen Union, der die Lebensbedingungen für Flüchtlinge verbessern könnte. In Jena leben diese in einer Gemeinschaftsunterkunft in der Nähe des Schillerhof-Kinos (S. 18). Die unique hat sie besucht und sich einige Eindrücke verschafft (S. 12). Einen der Bewohner sowie mehrere andere Neu-Jenaer haben wir zu ihren Alltagserfahrungen in der Saalestadt befragt (S. 10).
Zu sagen, dass es in Jena nicht ganz einfach ist, eine Wohnung zu finden, wäre eine maßlose Untertreibung. Das gilt für internationale Studenten aber noch in erhöhtem Maße. Welche Schwierigkeiten sie haben, bis sie einen Wohnplatz gefunden haben und wie sie in Thüringen auch jenseits des „Studentenparadieses“ leben, lest ihr ab Seite 20.
Eine Redakteurin der unique, die gerade ein Auslandssemester in Amsterdam absolviert, hat die Erfahrung der Wohnungssuche als internationale Studentin am eigenen Leibe erleben dürfen. Sie hat rasch eine Wohnung gefunden… oder besser gesagt: eine Bleibe. Von „Naumburger Straße“-Charme, gefährlichen Kühlschränken und interkulturellem Mit- und Nebeneinander in einem niederländischen Studentenwohnheim lest ihr ab Seite 8.
Das Bild, das sich Menschen vom „Fremden“ machen, wird ganz maßgeblich von der Sprache geprägt. Zwei Aspekte der Debatte über Integration und Zuwanderung in Deutschland diskutieren wir in dieser Ausgabe. Ein Wort, das diese seit Beginn der 2000er dominiert, ist der „Migrationshintergrund“, ein Begriff, der in den Medien und in der Alltagssprache wie natürlich genutzt wird. Ab Seite 33 geht es darum, wie hochproblematisch und sogar gefährlich er eigentlich ist. Wozu Stereotype über „Fremde“ führen können, haben nicht nur die Aufdeckung der terroristischen NSU-Morde gezeigt, sondern auch die ihr vorangehende Berichterstattung, die einen Niveau-Tiefpunkt mit dem Begriff der „Dönermorde“ erreichte. Eine studentische Forschungsgruppe der Universität Erfurt hat sich mit dieser Problematik im besonderen – und mit der Berichterstattung über Ausländer in thüringischen Medien im allgemeinen – befasst (S. 34).
Bewegte Bilder über Migrationsschicksale zeigt das Kino schon seit seinen Anfängen. Für alle diejenigen, die sich also auch nach der Lektüre der unique 61 für Aspekte des „Ankommens“ interessieren, hat die Redaktion zehn Filme ausgesucht (S. 23).
Ausgabe 60:

Auch im 21. Jahrhundert bleibt Pjotr Tschaikowski der berühmteste russische Komponist weltweit. Seine Kunst lebt für immer weiter, auch wenn sein eigenes Leben voller Turbulenzen gewesen ist – er war nämlich homosexuell. Russlands Gesetzgeber müssten nun eigentlich vor einem Dilemma stehen: Sind diese internationalen Konzerthallen-Erfolge „Propagierung von Homosexualität“? Das ist schwer zu sagen. Die Gesetze mehrerer russischer Gebiete, die diese nun verbieten, bleiben in ihrem Wortlaut wenig konkret, und ermöglichen daher ein Vorgehen der Staatsmacht gegen alle öffentlichen Äußerungen von homo-, bi- und transsexuellen Gruppierungen. Warum dies ein enormer Rückschritt für Russland ist, wenn alternative Lebenspartnerschaften (wieder) „außen vor“ bleiben müssen und ob der Mensch Tschaikowski heutzutage unerwünscht (неугодный) wäre, könnt ihr auf Seite 17 lesen.
Kürzlich wurde in Russland übrigens das „Deutschlandjahr“ eröffnet; es erinnert an ein Jahrtausend kultureller und gesellschaftlicher Beziehungen zwischen den beiden Ländern, jenseits von Krieg und Feindseligkeiten. Eine hierzulande fast unbekannte Facette russischen Kulturguts, nämlich die Verarbeitung einer deutschen Figur zu einem (vergessenen) Romanhelden, bringen wir euch auf Seite 31 näher.
Wenngleich manch ehemaliger Bundesfinanzminister die Kavallerie in die Schweiz schicken möchte, so kommt manch Schweizer mit viel friedlicheren Absichten nach Deutschland. Zum Beispiel Dieter Moor, der nicht nur sonntags titel, thesen, temperamente moderiert, sondern auch in Brandenburg als Bio-Bauer tätig ist. Was er eigentlich von dieser Kategorisierung und von anderen Dingen hält, hat er unique ausführlich dargelegt (Seite 24).
Während Dieter Moor aus freien Stücken seinen Wohnort über eine Grenze hinweg verlegt hat, musste Shirin Ebadi ihre iranische Heimat unter Zwang verlassen: Die Juristin hatte sich jahrelang für die Verbesserung der Menschenrechtslage vor Ort eingesetzt. Dafür wurde sie 2003 mit dem Friedensnobelpreis ausgezeichnet. Im Iran selbst war sie Repressalien ausgesetzt und entschied sich, im Exil (تبعید) zu leben. Shirin Ebadi war Anfang Mai in Jena, um den Preis für internationale Verständigung und Menschenrechte der Ulrich-Zwiener-Stiftung entgegen zu nehmen (Seite 8): eine ihrer zahlreichen Reisen für die Sache der Menschenrechte im Iran, die sie außerhalb ihres neuen Wohnorts Großbritannien führen. Als Frau könnte sie dort übrigens mit 60 in Rente gehen. Ganz anders die unique, deren 60. Ausgabe ihr in der Hand haltet: Wir widmen uns zwar in einem Beitrag den vielen Facetten dieser Zahl von A bis Z (Seite 32), denken aber nicht daran, in den Ruhestand zu treten. Als Bestätigung dafür konnten wir uns Anfang Juni über die Auszeichnung beim Wettbewerb „Miteinander studieren in Thüringen“ freuen, die wir vom Thüringer Ministerium für Bildung, Wissenschaft und Kultur verliehen bekamen. Dafür gilt unser Dank – neben unseren Förderern – natürlich euch als unseren treuen oder neuen Lesern. Euch wünschen wir viel Freude beim Lesen der nächsten nicht ganz 60 Seiten.
Ausgabe 59:

Eine Frau ist eine Frau ist eine Frau. Oder doch nicht? Jeder hat seinen Idealtypus des Weiblichen im Kopf, der eine mehr, der andere weniger zeitgemäß – am Ende entscheidet frau selbst, wer sie ist und wie sie gesehen werden will. Feministinnen und Ratgeberschreibern sei Dank, kann auch der letzte Patriarch erfahren: Frau ist nicht gleich, was er zu seinem Objekt macht. Und doch: Gendern ist an sich nichts anderes als die aktive Objektivierung der Frau. Der fast schon – wenigstens in deutschen akademischen Kreisen (Seite 30) – Genderwahnsinn ließ uns über die Grenzen Deutschlands hinaus fragen: (Wie) gendert die Welt? Antworten dazu findest du auf Seite 26.
Dass man nicht als Frau geboren, sondern zu ihr gemacht werde, erkannte Simone de Beauvoir und erschütterte damit die Vorstellungen der Männerwelt. Eine Frau ist kein geheimnisvolles Wesen, nur facettenreich. Einen ebensolchen Einblick in das Bild der Frauen, die Niqab tragen, erhaltet ihr ab Seite 11. Drei Frauen, ein Kleidungsstück und die Erkenntnis, dass man ihn aus Überzeugung trägt oder dem Zwang zuvor kommen will, um ihm irgendwann entkommen zu können. Am Ende steht das Verlangen nach Respekt – ihn tragend oder nicht. Eine künstlerische Auseinandersetzung mit dem Bild verschleierter Frauen findet ihr auf Seite 12. Diese Frauenbilder errangen den 3. Platz des zenith-Fotopreises 2011.
Dass nicht überall auf der Welt die so heftig geforderte Gleichberechtigung und damit auch Gleichbehandlung beider Geschlechter zufriedenstellende Umsetzung findet, ist ebenso wenig neu, wie die Tatsache, dass Reden allein nicht hilft. unique traf eine Mitarbeiterin der malaiischen NGO Empower, die Frauen durch Hilfe zur Selbsthilfe eine Stimme gibt (Seite 16).
Viele südostasiatische Frauen wissen sich selbst zu helfen: einen reichen Mann finden, heiraten und ein besseres Leben beginnen. So einfach scheint ihre Zauberformel, auf der eine ganze Industrie beruht. Heiratsmigration wird in der westlichen Welt als Skandal aufgefasst. Frauen, bar jeder Selbstbestimmung, werden wie Waren behandelt, so denkt man schnell und vergisst, was oft hinter diesem Phänomen steht. Eine Meinung über den westlichen Tellerrand hinaus lest ihr auf Seite 8.
Die Anzahl der Frauenbilder, sie überschreitet jede Zählbarkeit und doch bedarf jedes einzelne eines besonderen Blickes, denn ja, es ist schön eine Frau zu sein – weil sie ein Mensch ist, weil sie denken kann, sich abgrenzt oder einfügt. Hierfür bedarf es keiner gesonderten Endung.
Ausgabe 58:

Im Jahre 1837 schrieb Hans-Christian Andersen Des Kaisers neue Kleider. Zwar hat das Märchen um die „durchsichtige“ Mode des nackt herumstolzierenden Staatsoberhaupts inzwischen über 170 Jahre auf dem Buckel, doch an der Aktualität seines Inhalts nichts eingebüßt. Im moralischen Kern geht es um den Sieg wirtschaftlicher Erwägungen über die Wahrheit.
Wie viel von dem Geld, das H&M oder „der Textildiskont“ KiK einstreichen, bei der Näherin in Bangladesch ankommt, zeigen wir auf Seite 14. Bevor die Näherin aber ihre 70-Stunden-Woche beginnen kann, wird der Rohstoff Baumwolle in zwei stark gesundheitsgefährdenden und umweltschädlichen Verfahren geerntet und verarbeitet. Den Weg der komplexen Produktion könnt ihr auf Seite 16 nachvollziehen. Natürlich sind wir nicht die ersten, die sich diesen Zuständen kritisch nähern: Konsumkritik, kreativen Protest und die Entstehung einer „Verbraucherdemokratie“ erläutern wir unter soziologischen Gesichtspunkten (Seite 18). Und auch ein paar subjektive Denkanstöße wollen wir euch mitgeben: Ob man wirklich Chanel und Chinohosen im Kleiderschrank haben muss, erörtern wir auf Seite 9. Neuer Chic entsteht nämlich auch aus Upcycling. Was das ist, erläutert uns eine Designerin im Interview (Seite 22).
So widmen wir also dieses Heft der Kleidung. Ob wir damit etwas verändern können oder viele von euch nur ein weiteres Mal genervt die Augen rollen wegen der Dauerpräsenz des Themas? Bemüht haben wir uns jedenfalls um eine sachliche und vor allem informative Herangehensweise. Es geht um Tatsachen und Hintergründe dieser knallharten Branche und darum, wie man versucht, diese zu verheimlichen. Denn das eigentlich Schockierende sind leider kaum noch die miesen Arbeitsbedingungen selbst, sondern der unterkühlte Umgang mit ihnen. Oder haben Konzernbosse wie KiK-Chef Stefan Heinig gar keine andere Wahl? Denn im Gegensatz zu unserem Kaiser gibt sich der heutige Konsument eben nicht mit „durchsichtiger“ Kleidung zufrieden.
Ausgabe 57:
Unsere gewaltigen Investitionen in Wissenschaft und Forschung sind Ausdruck unseres Glaubens, daß die Wissenschaften den Menschen nicht nur reicher, sondern auch besser machen können.“ Der ehemalige US-Präsident Lyndon B. Johnson hat mit dieser Feststellung bis heute Recht. Die Wissenschaft ermutigt, ja fordert uns, Gängiges zu hinterfragen und gibt sich mit keinem Status quo zufrieden. Aber sie ist auch anfällig dafür, instrumentalisiert zu werden. Unsummen werden investiert; häufig nicht um des Fortschritts, sondern des bloßen Wettbewerbs willen. Wir haben einen Blick darauf geworfen, wie Wissenschaftsförderung bei ehemaligen und aktuellen “superpowers” funktioniert, welche historischen Hintergründe und Strukturen ihr zugrundeliegen (S. 14). Eine andere Form der Instrumentalisierung erfolgt tagtäglich auf den Sendern des weltweiten TV-Marktes. Das positive Image der Wissenschaft dient Fernsehmachern gern als Grundlage für Vorabendmagazine, die am treffendsten als Unterhaltungsratgeber bezeichnet werden können. Mit Formaten wie Galileo oder Brainiac lässt sich besonders ein junges, hedonistisches Publikum erreichen und bespaßen. Der Mehrwert für den Wissenssuchenden bleibt dagegen gering. Ein Kaleidoskop internationaler Populärwissenschaft findet ihr auf Seite 20. Dass Wissenschaft längst in der Mitte der Gesellschaft angekommen ist, hat sie unter anderem der immer kritischeren und umfangreicheren Printberichterstattung zu verdanken. Der Chefredakteur von Spektrum der Wissenschaft erklärt im Interview, warum eine Popularisierung wissenschaftlicher Erkenntnisse selbst von Seiten der Forschung immer stärker forciert wird (S. 16). Unleugbar ist die Fähigkeit der Wissenschaft, zu verbinden – zwischen Menschen, zwischen Ländern, zwischen Kulturen. Sie dient dort als Mittler, wo Sprache oder Gewohnheiten für Missverständnisse sorgen. Was aber passiert, wenn statt der verbindenden die trennenden Aspekte in den Vordergrund geraten, zeigen Gespräche mit ausländischen Forschern in Deutschland. Ab Seite 6 lest ihr, welche Probleme jungen Akademikern in der deutschen Wissenschaftslandschaft begegnen können. Über all dies darf aber nicht die große schöpferische Macht der Wissenschaft vergessen werden. Und so möchten wir euch für die Lektüre dieser Ausgabe noch folgendes Zitat der französischen Ex-Politikerin Simone Weil mit auf den Weg geben: „Ihrer wahren Wesensbestimmung nach ist die Wissenschaft das Studium der Schönheit der Welt.“
Ausgabe 56:

Wenn ein Kind zehn Jahre alt wird, steht in der Regel die Entscheidung an, auf welche Schule der Lebensweg führt. Ein zehnjähriger Hund hingegen kann schon auf einen stolzen Lebensweg zurückblicken, hat vielleicht noch ein paar glückliche Jahre auf dem Altenteil vor sich. Ihnen beiden ist eines gemein: Sie haben noch nie einige tausend Leser informiert, unterhalten, empört oder gelangweilt. Wenn eine Zeitschrift zehn Jahre alt wird, dann hat sie die Kinderkrankheiten überstanden und weiß auch schon, wohin der (Lebens-)Weg gehen soll – möchte man meinen. Tatsächlich aber stellen sich all diese Fragen immer wieder neu. Wie wir in der unique darüber streiten, wo wir mit der Zeitschrift hin wollen, kann man in einer ironischen Darstellung typischer Redaktionssitzungen nachlesen (S. 25). Das Magazin und seine Ansprüche haben sich im Laufe von zehn Jahren enorm verändert. Über die interkulturellen Anfänge sprachen wir mit dem ersten Chefredakteur (S. 28). Ohne die Unterstützung des FSU-StuRas wäre das Magazin niemals gegründet worden – aber in zehn Jahren bleiben Streitigkeiten nicht aus. Die Geschichte unseres Verhältnisses mit dem Organ beleuchten wir auf Seite 30. Wie interkulturell wir wirklich sind, haben wir versucht mit einer Statistik zu untersuchen. Das Ergebnis ist auf Seite 27 zu finden. Zwar interkulturell, aber völlig heruntergekommen war das Wohnheim für internationale Studenten in der Naumburger Straße, als wir vor einem Jahr dort waren. Wir wollten wissen, was sich dort seitdem verändert hat. Unsere neuesten Recherchen dazu findet ihr auf Seite 32.
Jetzt sind wir also zehn. Und siehe: Wir sind wie zehnjährige Kinder – und wie Hunde. Auch wir wissen nicht, wie es weitergeht. Wir ringen um unseren künftigen Weg, tasten uns dabei langsam vor, wie ein schnüffelnder Vierbeiner. Manchmal bellen wir laut, um vor Unheil zu warnen oder wir pinkeln jemandem ans Bein, der es verdient hat. Und manchmal produzieren vielleicht auch wir einen großen Haufen Scheiße.
Ausgabe 55:

Es steht schlecht um die Freiheit. Zwar ist sie in Nordafrika auf dem Vormarsch, aber immer muss sie sich verteidigen: Nein, sie sei kein neokoloniales Exportgut. Nein, sie sei nicht, was uns die FDP vorgaukelt (Steuersenkungen für Reiche, Verlängerungen der Atomlaufzeit). Und nein, sie wolle nicht von Islamisten missbraucht werden im Kampf gegen – naja, die Freiheit. Es gibt gute Gründe, eine Ausgabe der unique der Freiheit zu widmen, immer wieder: „Freiheit ist das Recht, anderen zu sagen, was sie nicht hören wollen“ (George Orwell) – ein Gedanke, den die Gespräche um die unique oft genug vermissen ließen. Nicolas Chamfort: „Die Fähigkeit, das Wort ,Nein‘ auszusprechen, ist der erste Schritt zur Freiheit.“ Ein Nein steht am Anfang aller Handlungen der berühmten Dystopien des 20. Jahrhunderts wie 1984 oder Brave New World, die uns das Leben in Unfreiheit zeigen, aber auch den mutigen Kampf Einzelner gegen die jeweiligen Regime (S. 30). Konkrete Einschränkungen der Pressefreiheit im ganz realen Deutschland fangen mit einem harmlosen Verwaltungsakt an, breiten sich aber zu einer handfesten Korruptionsaffäre aus (S. 21). Bei Korruption denkt man fast unweigerlich an Russland. Warum es dort eine ganz besondere Form der Freiheit gibt, zeigt ein Bericht aus Moskau (S. 10). Einen Appell, auch in Deutschland die Einschränkungen der Freiheit nicht hinzunehmen, spricht Juli Zeh aus im Interview über ihr Buch Corpus Delicti, die Entpolitisierung der Gesellschaft und staatliche Überwachung (S. 18). Dass nicht nur Staaten Überwachungstechnik einsetzen, sondern manchmal auch selbst überwacht werden, ist George Clooney zu verdanken. Er hat eine Internetseite erstellen lassen, in der jeder die Situation im vom Bürgerkrieg zerrütteten Sudan beobachten kann (S. 17). Während das Land seit Jahren um Frieden kämpft, ist der Kampf um die Überwindung der Apartheid in Südafrika seit den 1990er Jahren vorbei. Eine Kommission soll helfen, über Geschichtspolitik Zusammenhalt zwischen den für Jahrhunderte getrennten „Rassen“ zu stiften (S. 14). Jahrhunderte alt ist auch die Forderung nach Informationsfreiheit – der Kampf darum muss aber immer wieder neu geführt werden, wie der Fall Wikileaks zeigt. Ein Buch betrachtet das Phänomen aus verschiedenen Perspektiven und kommt zu interessanten Ergebnissen (S. 16). Wir hoffen, dass auch die Lektüre der unique zu interessanten Gedanken und Erkenntnissen führt und manche neuen Ideen bringt. Gerade das Thema Freiheit lädt zu Diskussionen ein, daher der Appell: Es schreibe Leserbriefe, wer denket, „nein, das stimmt so nicht!“ Wie gesagt: „Am Anfang war das nein.“ Der kundige Leser wird es merken, eine leichte Abänderung. Wir waren mal so frei.
Ausgabe 54:

Ausgabe 53:

unique Nr. 53 wurde finanziell unterstützt durch die Weimarer Stiftung Ettersberg zur vergleichenden Erforschung europäischer Diktaturen und ihrer Überwindung.
Ausgabe 52:

Während der Griesbachgarten zum alljährlichen Uni-Ascott lädt, sucht 300 Pflastersteine tiefer eine Handvoll Redaktdolleure hut- und blutlos nach dem passenden Gewand für die 52. Sammlung interkultureller Augenblicke. Die Verständigung verläuft nach dem Wortklotzprinzip: „Nudeln!“– „Bäh, Salz!“ Das spart Zeit und fügt sich adäquat zwischen zwei Vuvu-Kreischer ein. Von allen verunglimpft, muss man diesem einseitigen Jubelgedonner zugute halten, dass es auch den jenseits von TV und WorldWideWeb Wohnenden live über den Spielverlauf informiert. But what‘s in a goal? Ehe einen die füßische Hysterie ins Koksdelirium oder die Wände hoch zu treiben droht, sollte man sich vielleicht lieber in andere Klang- und Sprachwelten flüchten und mit groovigen Ohrwürmern die Torheit hinter sich lassen. Mit der richtigen Musik spricht es sich gleich viel leichter. Dagegen sind die verbliebenen Zeitungsbastler über Omas erkalteter Möhrensuppe und den graumelierten Ausdrucken bunt bemalter Eisenbahnwaggons inzwischen endgültig verstummt. Ob aus anämischer Sommerträgheit, Nostalgie oder banger Erwartung des nächsten Morgens lässt sich nicht genau sagen. Doch der Paukenschlag um Mitternacht hat noch nie seine Wirkung verfehlt. Gleich pochen die Schläfen wieder und der Satz segelt sicher gen Ende.
Ausgabe 51:

Sieben Monate bin ich nicht mehr aus gewesen, in meiner Stammkneipe gab’s scheinbar nur noch billigen Rotwein. Dafür hab’ ich abgenommen, meine alten Anzüge passen mir wieder. Nun sitze ich zufrieden in der neuen gemütlichen Bar um die Ecke, der letzte Gedanke spiegelt sich im leeren Glas. Hinterm Tresen tapeziert jemand ein Jahrzehnt Hip-Hop an die Wände, während sich draußen britisches Geflügel durch unnatürlich starke Winde kämpft. Ein Schwein, wer Böses dabei denkt. Nick bringt mir Bismarckhering mit Bohnen. Höflich, wie ich es gelernt habe, sage ich erst einmal Dankeschön, füge dann aber lachend hinzu, dass es sich wohl um ein irrtümliches Gastmahl handeln muss, hatte ich doch Eisbein mit Bärlauch bestellt. Während auf dem Flachbildschirm über dem Eingang ein Bericht zur kommenden Weltmeisterschaft läuft, glotzt der ausgestellte Löwenschädel daneben domestiziert von der Wand. Ich muss mal. Vor der Toilette heißt es warten. Eine ewige Schlange. Und trotzdem komm’ ich gern hierher – Hausnummer 51 gehört einfach irgendwie dazu.
Ausgabe 50:

Vorbei die schönen Sommersonnenstrahlen. Der raue Herbstwind treibt das goldene Laub über die Wege und euch einen Meilenstein in die Hände: 50 Jahre UNIQUE! Zeit, wo bist du hin? Natürlich hinterlassen die Jahre ihre Spuren, darum: Das Ganze jetzt in neuem Format – und natürlich besser als jemals zuvor. In jedem Fall ein Grund zum Feiern. Aber danach zurück an die Arbeit, denn es gibt viel zu tun. Erst kürzlich gab es wieder eine öffentliche Debatte über Deutsche mit Migrationshintergrund, die laut Bundesbankvorstand Thilo Sarrazin unter anderem „ständig neue kleine Kopftuch-Mädchen“ produzieren. Das personifizierte Böse, das Ende der multikulturellen Gesellschaft ist möglicherweise vier Jahre alt, dunkelhaarig und trägt Kopftuch – Spieglein, Spieglein an der Wand, wer hat Angst vorm Morgenland? Bist auch du islamophobique? Eine Auseinandersetzung mit solchen Ängsten scheint überfällig zu sein. Damit ihr die wichtigsten Argumente gegen islamfeindliche Vorurteile immer griffbereit habt, gibt’s diese im praktischen Hosentaschenformat auf Seite 17. Wer es weniger brisant und dennoch aktuell mag, der kann mit unserem Kulturteil den Blick aus dem Fenster ergänzen und seine herbstlich-trübe Stimmung zelebrieren – denn Melancholie ist das Vergnügen, traurig zu sein. Dazu gibt’s natürlich alte interkulturelle Bekannte, Gedanken und Geschichten von New York bis Pößneck, Gespräche mit Muslimen, Medienwissenschaftlern und jungen Polizistinnen – alle versammelt in diesem herbstlich bunten Blätterwald in euren Händen.
Ausgabe 49:

Liebe Leserinnen und Leser! Die Semesterferien rücken in greifbare Nähe, die Koffer sind gepackt, der intellektuelle Reiseproviant liegt frisch gedruckt in Euren Händen. Was kann da noch schiefgehen auf dem Weg zum lang ersehnten Urlaubsparadies? Eine ganze Menge, wie wir feststellen mussten, als wir in die azurblauen Tiefen der touristischen Thematik eintauchten. Längst sind die romantischen, einsamen Domizile der Südsee nicht mehr das, was Hagenbecks Völkerschau einstmals dort vorgefunden hätte. Fast überall werfen Reiselustige nicht nur ihre Handtücher auf begehrte Plastikliegen – um sich dann unter mehrmaligem Wenden bis zur gewünschten Intensität zu bräunen – sondern auch Sand ins Getriebe von Mutter Erde. Der Massentourismus beeinflusst schließlich nicht nur die Fernreisenden und neidischen Daheimgebliebenen, sondern auch die Ziele ihrer allsommerlichen Invasionen. Quo vadis, deutscher Touri? Wer es weniger massig und dennoch touristisch mag, findet hoffentlich ein schattiges Plätzchen mit unserem sonnigen Blättchen. Doch keine Angst: Auch diejenigen unter euch, deren touristischer Horizont oder studentischer Geldbeutel nicht ganz so weit reicht, wollen wir nicht allein mit Hochglanzpostkarten auf Balkonien versauern lassen. So findet sich hoffentlich für jeden Dauercamper, Katastrophentouristen oder Vielflieger ein passendes Ziel oder zumindest eine brauchbare Alternative zur Fernweh-Epidemie. Eine gute Reise wünscht die UNIQUE-Redaktion.
Ausgabe 48:
Die Verzweiflung steigt in dem Maße, in der die Zeit verrrinnt. Was haben wir nur wieder alles vereitschustert? Amadeus rockt in griechischem Gewand im mikrokleinsten Garten, die Lusaner Betten quietschen um die Wette, da gerinnt der schleimigste Sexismus in Titeln und Spalten, und so ziemlich jede Sauerei wird durch den redaktionellen Stall gejagt – na so geht das aber nicht! Daher nun – Contenance, meine Herren und Damen! – noch ein letzter Versuch: Sexismus fängt ja im Kleinen an. Wie wäre es also damit: Suchen kinderlieben, mindestens trisexuellen Putzmann, der hier mal wieder ordentlich durchkehrt und alles Skandalöse und all die stinkenden Pestilenzleichen unter den Tisch kehrt. Und wenn er/sie/es schon einmal dabei ist: Bitte das antifaschistische Konfetti auf dem Campus nicht vergessen, sollte es noch nicht vom Winde verweht sein.Andererseits: Nur 0,001 Prozent aller Jenaer Bürgerinnen sprechen Kalmückisch – ob sie unter Emanzipation dasselbe verstehen wie wir? Nein, stellten sie uns den Gerstensaft doch gänzlich diskriminierungsfrei vor den Bauch und freuten sich auch sonst ihrer drallen Weiblichkeit. Wozu also der ganze Terz? Mann bleibt eben Mann und Frau bleibt Frau, davor schützt alle Studier(ender)theit nicht.
Ausgabe 47:
Lange haben wir sie gesucht, sie erforscht und versucht, ihr Geheimnis zu ergründen … und sie dann wohl doch nicht gefunden. Der Morgen bricht an, die Flaschen sind leer, hinter den doppelten Fenstern der Redaktion zeichnet sich weiterhin die altvertraute Silhouette Jenas ab. Haben wir sie längst gefunden, die heile Welt, hier zwischen deutschbewaldeten Muschelkalkhängen? Zweifel sind angebracht! Fahrig, auf der Suche nach kleinsten Fehlern und letzten Unachtsamkeiten, gleitet flink die Maus über den Tisch, während sich Nazis, Plattenbauparzellierte und Inzestopfer auf zerwühlten Nachtlagern wälzen, rastlos von einer besseren Welt träumend. Die Nacht gebiert Illusionen und Utopien, die geladene Waffen zerschießen. Wer schreibt eigentlich den Soundtrack des Lebens, der uns alle in entspannte Zufriedenheit entließe? Nicht Gott, nicht Morus, auch der edle Wilde nicht. So bleiben am Ende doch nur wir.Und dann, ganz kurz, verstummen sie doch, die ewigen Debatten und Polemiken. Die Linie stimmt, die Kontur wird erkennbar. Heile Welt gerinnt in 32 Seiten glänzenden Papiers. Selbstvergessen sinke nun nieder, den flüchtigen Augenblick zu genießen!
Ausgabe 46:
Zwischen Das-tragen-Stars-am-Arsch und Dieter-mach-uns-Kinder-in´-Kopf im Vorbereitungs- programm künftiger Mediaassessoren naht der „neue Potter“ mit rasender Neuauflage. Bitte was? Ist doch schon jedem passiert. Aus Versehen den Fernseher mal an einem Wochentag angeschaltet, den Logoutboutton am Postfach zu fest gedrückt, der Sendersuchlauf bleibt im Bundeswelle-Radio stecken, und schon ist der Tag im Eimer. Schon quillt einem ein unverortbarer Brei an alle primären Sinnesorgane, stellt klebrigen Kontakt mit alten, gut eingesitzten Assoziationsmustern her und wölbt sein schleimiges Unnütztum kuppelartig über unsere Schalthemisphären. Ahhh! Who is my guide through the Niemandsland Verbraucheroptimierter Themenwahl, nach dem sich Nachrichten richten? Welcher kosmopolitisch Ambitionierte kann noch die richtigen Fragen finden hinter den tausend Wahrheiten westredaktioneller Brauchtumspflege? Der Deutsche Fernsehpreis 2tausend12 geht an: Das zweiteilige TV-Drama: „Alles Aus – Media und Presse trennen sich!“ und „Eine neue Vorliebe ist wie ein neues Leben – Media mit Meinung im Bett erwischt!“ Und zum Geleit noch ein Verbesserungsnachtrag für den Wikipediaartikel Medienkompetenzen: „Druckerpressen – Nationalismus scheiterte am Grundsatz“
Ausgabe 45:
Die Operation, die ist immer so. Auch die Zeit wird dringend aufgefordert. Die Missstände und Ungerechtigkeiten haben sich geändert – und wenn sie eilig und „blind“ Menschen verurteilen. Drauf geschissen. Wie wäre es mit einer der – oha, sehr schwierigen! – Unsicherheiten und täglichen Krisen des Glaubens? Lassen sich solche Fragen überhaupt diktieren? Vielleicht ist der Versuch zur Klärung der Angelegenheit nach Jena zurückzukehren nichts unbedingt Schlechtes. Unter Brücken und Lobeda ist viel Platz. Nein, nicht unbedingt für TVSpots, in dem sich der offiziell neunte Baggerfahrer in einem halben Knoppers-Cockpit in 50 Meter Höhe gemächlich zuruck-, äh, zurücklehnt. Es gibt wahrscheinlich eher Augen, die eine besondere Bedeutung für Ideologen haben. In der aktuellen Ausgabe haben wir einige neue Abschnitte, getrieben von der Wahrnehmung, dass sich die Dinge nur im kleinen ändern lassen. Wenn überhaupt indirekter. Nach dem Interview mit Reverend Luther King folgt laufend das „Brown House“ in Old-Lobeda sowie seine extremen politischen Vertreter. Die unterschiedlichsten Meinungen, mehr Konkurrenz, nicht geklärte rechtliche Fragen. Subversivste Banalitäten und Bananen. Und die eheliche Gleichstellung mit der Schwangerschaft. Auch die! Daher sollten alle immer nett zueinander bleiben. „Aktiv und glücklich lesen“ lautet nun die Devise. Wir hoffen, dass die Formulierung verstanden wird. Wenn nicht, kauft die Weltbank. Atem und viel Kraft im neuen Jahr wünscht die UNIQUE-Redaktion.
Ausgabe 44:
Student-Sein ist nicht einfach. Erst begreift man, dass Soziologie doch nichts mit Tieren zu tun hat und man für Informatik doch Ahnung von Mathe haben muss, um einige Semester später zu erkennen, dass auch der Prof. Dr. Dr. rer. soc. phil. habil. kein neuer Bildungsmessias ist. In der WG erzählt einem der rastahaarige Freund der Mitbewohnerin von den Verstrickungen eines gewissen Herrn George Soros in die internationale Finanzkrise, welcher auch noch Mitglied in der selben transatlantischen Soligruppe wie der besagte Professor ist. Im Fernsehen läuft die hundertste Wiederholung einstürzender Hochhäuser, nur unterbrochen von den Breaking News, dass auch heute der DAX wieder dramatisch abgestürzt, gestiegen oder auf unverändertem Niveau geblieben ist. Vor der Tür predigt unterdessen eine älteres Pärchen im Filzmantel, lädt zum gemeinsamen Kennenlernabend ein und hinterlässt ein kleines Heftchen im A5-Format. Ob es nun die Wiederkehr Jesu, des Mahdi oder eurer teuren mit Rotwein bekleckerten Bluse aus der Wäscherei ist, auf die ihr wartet, die Unique-Redaktion hat versucht, sich ein wenig durch den Glaubensdschungel zu schlagen. Dabei trafen wir auf alte und neue Götzen von Adam Smith bis Friedolin, von Freddie und Fannie bis Jesus, von Nietzsche bis Obama. Für den wahrscheinlichen Fall, dass ihr am Ende der Lektüre verwirrter seid als zuvor, findet ihr auf Seite 22 einen Überblick über Möglichkeiten, eure persönliche Krise in Alkohol zu ertränken und auf der Rückseite einen persönlichen Plüschmessias zum Selbstausschneiden.
Ausgabe 43:
Die Blätter haben zu fallen begonnen und die Sonne versinkt viel früher als sie sollte am Horizont: Herbst. Eine Zeit, die nicht nur in der Natur den Umbruch verspricht. Im Herbst beginnt das neue Semester und das bedeutet nicht nur einen neuen Stundenplan, sondern auch neue Gesichter, neue Eindrücke, neue bislang unbekannte Gefühle. Im Herbst packt uns die Sehnsucht nach etwas Neuem, Unaussprechlichem, aber auch die Wehmut, nach dem, was mal war und nie wieder kommen wird. Man will weit weg oder einfach wieder nach Hause, wobei beides manchmal einfach nicht zu machen ist. Heimweh und Fernweh sind wohl die schlimmsten Sehnsüchte, denn sie werden niemals ganz verschwinden. Doch denkt mal darüber nach: Jede geschlossene Tür, lässt dich das ohne Fenster besser wahrnehmen. Willkommen im neuen Semester und zu einer neuen Ausgabe der Unique.
Ausgabe 42:
Es war ein Tag, an den man sich lange zurück erinnert. Ich stand auf, zog mich an, ging in die Stadt und schaute kurz in der Redaktion vorbei. Es war Sonntag, die Läden waren wie gewöhnlich geschlossen und ich hatte Hunger. Es war einer dieser Sonntage, an dem ich mich immer ärgere, dass ich am Samstag zuvor nichts eingekauft hatte. Eigentlich gehe ich nicht gerne zu Mc Donalds aber was essen muss man ja, denke ich mir dann immer. Meistens esse ich Cheeseburger -die haben einfach das beste Preis-Leistungsverhältnis, nur eine Gurkenscheibe mehr könnte ruhig drauf sein. Seitdem die Kalorieangaben auf den Rückseiten der Tablettauflagen stehen, habe ich im Anschluss an meiner sonntäglichen Mc Donalds Besuche immer den Drang Fahrrad zu fahren, obwohl ich eigentlich keine Ahnung habe, was diese Zahlen bedeuten. Aber es soll wohl viel sein, habe ich gehört. Letztendlich war ich aber satt und das ist ja das Wichtigste. Nur Milch habe ich nicht bekommen, darüber ärgerte ich mich schon etwas. Viel Spaß beim Lesen und guten Appetit wünscht die Unique-Redaktion!
Ausgabe 41:
Neulich in der Redaktion beschlutz G. die Einredung auf Aufgebung dessen weniger.
1640 – Schweden zerstören am 13.3. ERNEUT die Camsdorfer Brücke.
Wir fordern Freiheit für den Bienenwolfkönig und auch ohne zionistische Tibermönche lassen wir es uns nicht nehmen, polemisch zu sein. Und gerade trotzdem bleiben wir, weil wir es lieben und es warm ist. Vielleicht hatte er doch Recht, Louis XVI., doch bis dahin schweigen wir so laut und lange „Mikrokosmos!“, wie wir können. Denn dieses Heft ist ein Hoch auf die Vielfalt der Provinzialität, ein Bekenntnis zu unserem Weltdorf.
Feierabend!
Ausgabe 40:
Feste feiern, wie sie fallen oder fallen nach dem feste Feiern. Der Morgen danach erweckt oft das Gefühl der Reue. Wir können Euch zwar nicht den Kater, jedoch das schlechte Gewissen nehmen und versichern Euch: Ohne Feiern kein Mensch. Feiern ist weitaus mehr als den Strohhalm in den Sangriaeimer halten. Feste sind tief verankerte Rituale der Menschheit. Es gibt uns das Gefühl der Gruppenzugehörigkeite, und wenn auch sonst angeblich die Tradition mehr und mehr löten geht, Weihnachten bleibt Weihnachten und zum Geburtstag wird zumindest angestoßen.
Dabei sei jedoch nicht das Gefühl erweckt, jedes Fest versprühe nur Fröhlichkeit. Die Unique-Redaktion hat sich Vorder- und auch Rückseite der festlichen Tradition angesehen.
Ausgabe 39:
Woher kommt eigentlich die Redensart: „Du wirst schon noch dein blaues Wunder erleben.“? Wird der Angesprochene bald blaue Flecken wegen seines etwaigen Verhaltens davontragen? Bezieht sich der Ausspruch auf den körperlichen Zustand nach exzessivem Alkoholgenuss, bei dem man ja gerne auch mal ein Wunder sieht? Diese Frage konnte auch das Redaktionsteam nicht zufriedenstellend beantworten. Allerdings waren wir mehrheitlich der Ansicht, dass sich in unserem Leben viel zu wenig mit der Farbe Blau auseinandergesetzt wird. Immerzu muss dieses harmlose Adjektiv für eher negativ konnotierte menschlichen Zustände wie Blausein, Blaumachen oder Blauschlagen herhalten. Um dem Blau eine Plattform zu bieten und ihm die Chance zu geben, sich in allen möglichen Facetten entfalten zu können, entstand diese Ausgabe. Bei der Gestaltung gingen uns ausgewiesene Experten wie Papa Schlumpf, Käpt´n Blaubär und der blaue Power-Ranger zur Hand.
Viel Spaß beim Lesen wünscht das Redaktionsteam aka „Die Blauen Panther“
Ausgabe 38:
Ob nun im oder beim Verkehr, ob im Beruf oder im Privatleben, immer gilt die Devise: Safety at first! Und das besonders für uns sicherheitsverliebte Deutsche. Bei uns gibt es Warnschilder für absolut jede Alltagssituation. Ganze Industriezweige beschäftgen sich mit dem Schutz vor realen und eingebildeten Gefahren. Bei dieser täglichen Bedrohung sollten wir jeden Abend dankbar ins Bett sinken, weil wir mal wieder einen unter Umständen tödlichen Tag überlebt haben. Dann fällt uns allerdings ein, dass die meisten Unfälle zu Hause passieren, die Nacht die Tageszeit der Diebe und Sittenstrolche ist, die Gefahr von terroristischen Attentaten auf Wohnhäuser rund um die Uhr besteht, Elektrosmog und Luftverschmutzung allgegenwärtig sind und die Klimaerwärmung mit Sicherheit dazu geführt hat, dass sich ein alles vernichtender Tsunami auf den Weg direkt in Deutschlands Mitte gemacht hat. So, jetzt erstmal ganz tief durchatmen. Entspannt Euch lieber in den letzten paar Stunden, die Euch noch auf dieser schönen Erde bleiben. Und das tut Ihr am besten mit der neuesten Ausgabe der Unique.
Gefahrloses Lesen (ob nun im oder außerhalb des Luftschutzkellers) wünscht Eure Unique-Redaktion!
Ausgabe 37:
Täglich bewegen wir uns innerhalb unserer geistigen und körperlichen Leistungsfähigkeit, werden determiniert durch gesellschaftliche Normen und Regeln, hangeln uns entlang den Grenzen des guten Geschmacks.
Himbeereis zum Frühstück? Ungewöhnlich. Laut zu “Your my heart, your my soul“ mitsingen? Grenzwertig. Eva Herrmanns Ansichten über Hitlers Familienpolitik teilen? Grenze ganz klar überschritten. Unser Alltag besteht also aus Mauern, Zäunen, Hindernissen und sozialen Stolpersteinen. Die meisten agieren sicher innerhalb der ihnen gesteckten Grenzen. Andere stoßen ab und zu mit ihrer Nase an selbige. Und einige Wenige wagen den Schritt, reißen die Barriere mit dickem Schädel oder nicht zwangsläufig dickem Hintern ein und betreten Neuland. Diesen Helden des Alltags soll diese Ausgabe gewidmet sein. Allen anderen geben wir den guten Rat mit: „Hinterm Horizont gehts weiter!“.
Wir wünschen Euch viel Spaß beim Grenzen setzen, Grenzen wieder einreißen und natürlich LESEN!
Ausgabe 36:
Heute schonmal länger als zum Zähne putzen in den Spiegel geschaut? Am Schaufenster besonders langsam vorbei geschlendert und das Augenmerk weniger auf die nett angezogenen Püppchen innerhalb, sondern eher auf die außerhalb der Scheibe gerichtet? Im Shampooregal entgegen jeglicher finanzieller Vernunft zum Teuersten gegriffen? Ertappt? Bestimmt. Das macht nichts, sagt sich das UNIQUE-Redaktionsteam und gesteht sich ein, dass jeder früher oder später einmal Opfer der eigenen Eitelkeit wird, auch wenn es nicht jeder zugibt. Schließlich ist das Äußere unser Erkennungszeichen, und die Kleidung, die wir tragen, das Make-up, das wir verwenden, denSchmuck, den wir anlegen, all das ist Teil unserer Identität.
In dieser Ausgabe zeigt sich, dass schön nicht gleich schön ist und in verschiedenen Ländern auf verschiedene Weise verschiedenen Idealen nachgeifert wird. Dabei spielt die Gesundheit leider oft eine untergeordnete Rolle.
Wir wünschen Euch trotzdem viel Spaß beim Kämmen, Schminken und natürlich LESEN!
Ausgabe 35:
Wer kennt noch die Situation, wenn an einem gemütlichen Spieleabend mit Freunden, die Stimmung zu kippen droht, weil Tobias nicht einsieht, dass man eben nicht klopfen darf, bevor man ausgelegt hat und es auch kein schlagendes Argument ist, dass bei ihm zu Hause, das schon immer so gespielt wurde? Und es ist dann auch immer jemand dabei (meist ist dieser Jemand weiblich und rehäugig) , der glaubt, der Abend und auch die Freundschaft wäre zu retten mit dem Satz: “ Mensch, regt euch doch nicht so auf. Ist doch alles nur ein Spiel.“ Dass das Spiel besser nicht zu unterschätzen ist, wird klar, wenn man Löwenbabys beobachtet, wie sie durch das Spielen mit ihren Geschwistern lernen, zu töten. Oder, noch drastischer: Wenn man sieht, wie baumstammstarke Männer beim Anblick der Niederlage ihres Fußballclubs in herzzereißendes Heulen ausbrechen. Wir haben uns in dieser Ausgabe mal Gedanken über das Wesen des Spiels gemacht.
Lasst den Spieltrieb raus!
Ausgabe 34:
Endlich ist er da, der Frühling. Ab geht es in den Paradiespark, auf den Balkon oder auch ins Bettchen? Denn bekannterweise bringen die ersten Sonnenstrahlen neben guter Laune und Sommersprossen auf der Nase auch die Frühjahrsmüdigkeit mit sich, die dann wahlweise auch auf Sommer, Herbst und Winter ausgedehnt werden kann.
Und da die Augen zu schließen nicht gleich Langeweile bedeutet, liefern wir Euch druckfrisch alles rund um das Thema Schlaf. Wer nicht beim Lesen eingeschlummert ist, dem fällt vielleicht auch auf, alles neu macht der Mai diesmal auch bei der Unique. Lasst Euch nicht vom neuen Layout irritieren, genießt den Sommer und…
…immer die Augen offen halten.
Ausgabe 33:
Das neue Jahr ist endlich da! Und auch in diesem Jahr wird alles besser als im letzten. Dabei helfen uns vor allem eine Reihe guter Vorsätze, die von Zigarettenabstinenz bis hin zu Weltrettungsvisionen reichen. Auch unser Redaktionsteam hat sich einiges vorgenommen. Da wären zum Beispiel das Sauberhalten der Büroräume, die Einhaltung des Redaktionsschlusses und die gesündere Ernährung an Satzwochenenden. Aber der wichtigste von allen Vorsätzen ist der, noch bessere Ausgaben für Euch bereit zu stellen. Damit fangen wir auch gleich an. Wir wünschen Euch viel Spaß mit unserer Umweltausgabe, die sicherlich auch ein paar Anregungen für die bietet, die sich vorgenommen haben, die Welt zu verbessern. Aber auch allen anderen sei die Lektüre wärmstens empfohlen.
Viel Spaß beim Schmökern und Frohes Neues Jahr (welches zu wünschen nie zu spät ist).
Ausgabe 32:
Die dunklen Monate sind angebrochen. Manch einer verfällt in einen lethargischen Winterschlaf, der andere beginnt sich dank Lebkuchen und Glühwein mit einem dicken Fell vor dem Erfrieren zu schützen, wieder andere suchen die gesellige Runde, um vorweihnachtlichen Riten zu frönen. Egal, wie Ihr euch entscheidet, etwas zum Schmökern versüßt so manche Stunde in der Dunkelheit. Die Kerzen aus der Schrankecke wieder rausgekramt, ein Räuchermännchen zum Dampfen gebracht und schon ist jede To-Do-Liste vergessen. Ist dies doch die perfekte Jahreszeit, einmal inne zu halten, den täglichen Stress zu vergessen und an sich und seine Lieben zu denken. Doch Vorsicht: Kerzen wieder auspusten, bevor die vorweihnachtliche Stimmung noch durch einen Wohnungsbrand ruiniert wird!
Ausgabe 31:
Wieder einmal hat ein neues Semester begonnen. Nach dem Sommerloch treffen in Jena die Alt- und Neustudenten ein und spinnen ihre Netzwerke. Die mit der 9 als erster Matrikelnummer, um ihren Start ins neue Leben zu vereinfachen, die mit der 6, weil sie mittels Kontakten vielleicht einen der seltenen Studentenjobs bekommen wollen und die mit der 3, um Kommilitonen zur Prüfungsvorbereitung zu finden. Auch außerhalb der Uni profitieren wir ständig von Netzwerken, sei es auf fetzigen Tupper- oder biederen Netzwerkpartys. Die UNIQUE bietet euch diesmal Einblicke in die Welt der Netzwerke, die euch vielleicht irgendwie das Leben versüßen, denn in einer Gruppe aus Gleichgesinnten wirken die großen und kleinen Probleme des Lebens nicht mehr gar so dunkel und grau wie der anstehende Herbst.
Ausgabe 29:
In dieser Unique widmen wir uns dem (zweit?-) wichtigsten menschlichen Grundbedürfnis: dem Essen. Um kein anderes Thema rankt sich so viel Kultur und Unkultur. Grund genug für die Unique, kräftig zuzuschlagen und sich so allerhand Leckereien einzuverleiben. Auch Dir, geneigter Leser, soll der Blick über den Tellerrand ermöglicht werden, wenn sich in unserer Leib- und Magen-Ausgabe spektakuläre Artikel türmen wie das Bratgut neben dem heimischen Grill. Doch genug der Hochstapelei: in dieser Ausgabe gibt es Infos und Überlegungen über das Essen, das Nicht-Essen und das Besser-nicht-Essen hier und woanders. In diesem Sinne: es ist angerichtet! Apropos: Im Camouflage-Mäntelchen getarnt erkennt man beim zweiten Blick ein falsches Würstchen!
Ausgabe 28:
Dreikommazweizwei – nein, das ist keine Promilleangabe oder eine Aussage über den durchschnittlichen Kinderwunsch im weiterhin CDU-regierten Thüringen! Das ist der Anteil der ausländischen Mitbürger oder Menschen mit Migrationshintergrund, die in Jena wohnen, arbeiten, leben… Wie aber leben diese Menschen? Welche Erfahrungen haben sie gemacht?Welche Integrationsmöglichkeiten gibt es? Wie integriert und “angekommen” fühlen sie sich selbst in unserer Stadt? Was heißt überhaupt Integration? – All das sind Fragen, denen sich die aktuelle Ausgabe der UNIQUE widmet!
Was außer einem UNIQUE-spontan-Grillfesten inklusive Fotoshooting von und für Ausländer in Jena getan wird, was sie her treibt und was sie hier treiben, das könnt ihr selbst in einer freien Minute in diesem Heft nachlesen. Zum Beispiel während eure Freunde den Grill befeuern oder das Volleyballnetz aufspannen….
Ausgabe 27:
Jena…wir haben ein Problem! Wie sage ich’s richtig, wenn mein Gegenüber von einem anderen Planeten (oder zumindest aus einer anderen Kultur) stammt und keine Ahnung hat, was man ihm mitteilen möchte? Schlimmer noch, wenn die Kommunikation aneinander vorbeiführt, man sich zwar verständlich machen will, aber nicht verstanden – im günstigeren Falle noch missverstanden – wird? Damit ihr nicht in die Fallen interkultureller oder sonst wie gearteter Vermittlung tappt, hat sich eure UNIQUE-Redaktion diesmal überlegt, das Thema ‚Kommunikation’ genauer unter die Lupe zu nehmen. Gänzlich metakommunikativ ohne Netz und mit viel doppelter Bedeutung. Falls die Grenzen der Lingua franca Englisch dann nämlich doch einmal ausgereizt sind, macht den großen Gesten-Erkennungs-Test: Eine Anleitung zum nicht Missverstehen. Viel Spaß also mit der neuen Ausgabe!










































